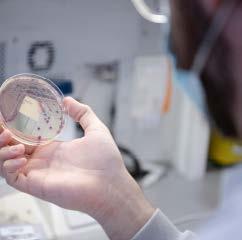

1 1 Quality Account 20222023
Introduction from the chief executive
Statement of directors' responsibilities
About this report
Governance arrangements
Care Quality Commission rating
Priorities for quality improvement in 202324
Statement relating to the quality of care provided
Progress against priorities set for 2022-23
Our patients
y Infection prevention and control
y Quality improvement
y Patient experience and engagement
y Our Patient Panel
y Improving care for vulnerable patients
y Learning from safety incidents
y Improving medicine safety
Our people
y Recognising our amazing people
y The national NHS Staff Survey
y Equality, diversity and inclusion
Our performance
y Performance against NHS constitutional standards
y Participation in clinical audits
y Research and development
Our places
y Improving our estate
y Environment and sustainability
Statements from stakeholders
Glossary of terms
Appendix 1 - Statements of assurance from the Board – prescribed information
Introduction from the chief executive
Welcome to the Quality Account 2022-23 for The Princess Alexandra Hospital NHS Trust (PAHT). Our year has continued to be one with a clear focus on quality care for our patients. It also has involved a significant level of hard work to recover from the impact of COVID-19 in terms of setting appointment schedules and delivering care to people who have experienced delays. My thanks go to all the teams at PAHT who each play an important part in ensuring our patients receive the quality care they need.
The Care Quality Commission (CQC) have completed a focused inspection of our urgent and emergency care (UEC) services. I am delighted to let you know that this inspection has resulted in a CQC rating improvement in our emergency department (ED) and the removal of the section 31 notice put in place in 2021. This positive move forward is the result of transformational change in the way our emergency department operates and the hard work of the team in making a difference. Although we have more to do it is very encouraging to see the impact of the work already in place.
Another piece of positive news, that has come from the Government, is that our plans for a new hospital will be fully funded. This is a great update and we now await the details of the funding, schedule and timetable for the new build using a shared hospital design across the country from the New Hospital Programme.
Similarly, we have secured funding for our new electronic patient records system and the project is being launched in July (2023) for delivery in autumn 2024. This project and the new hospital are key objectives within the PAHT2030 strategy to make
PAHT a modern, integrated and outstanding organisation. Although not all of our quality objectives are complete, four of our key improvements are:
y Our performance – outpatient improvement programme
y Theatre transformation
y Medicines optimisation
y Improving our clinical areas and critical functions
Again, much effort and hard work has been involved in these quality improvements and we are continuing to develop further changes too.
The improvements and quality care our teams provide are recognised on a daily basis by our patients, relatives and visitors in the many letters and messages of thanks received by our patient experience team. There has been a huge 70% rise of compliments with 949 compliments received in 202223, an increase from 559 in 2021-22. Congratulations to the people of PAHT in this achievement.
I am proud of our achievements and commend this Quality Account to you, and, as always, I am grateful to the many people who continue to provide high quality care and who have contributed to this report. I confirm that, to the best of my knowledge, the information and details in this account are accurate.
Best wishes
Lance McCarthy Chief executive

2 3 3
Contents
3 4 4 5 5 7 8 13 21 21 26 30 33 35 37 41 47 47 51 52 54 54 58 66 68 68 69 72 76 81
Statement of directors’
responsibilities in respect of the Quality Account 2022-23
The Trust directors are required under the Health Act 2009, amendments published in the Health and Social Care Act 2012 and the Quality Account FAQ published 2021/2 Annex 1, to prepare Quality Accounts for each financial year.
The Department of Health has issued updated guidance on the form and content of annual Quality Accounts, which incorporates the above legal requirements.
In preparing the Quality Account, directors are required to take steps to satisfy themselves that:
y The Quality Account presents a balanced picture of the Trust’s performance over the reporting period y The performance information in the Quality Account is reliable and accurate
y There are proper internal controls over the collection and reporting of the measures of performance included in the Quality Account, and these controls are subject to review to confirm that they are working effectively in practice
y The data underpinning the measures of performance reported in the Quality Account is robust and reliable, conforms to specified data quality standards and prescribed definitions, and is subject to appropriate scrutiny and review. The Quality Account has been prepared in accordance with Department of Health guidance.
The directors confirm that, to the best of their knowledge and belief, they have complied with the above requirements in preparing the Quality Account.
By order of the Board
About this report
What is a Quality Account?
Every year all NHS hospitals in England must write a report for the public about the quality of their services; this is called the annual Quality Account. The purpose of the report is to make the hospital more accountable to you and drive improvement in the quality of our services.
In 2022-3, COVID-19 has continued to influence how all NHS organisations organise care whilst recognising that in the future the Trust accepts this is in a business as usual context.
At The Princess Alexandra Hospital NHS Trust, we are committed to making sure that we keep our patients and our people safe. Our focus has been to ensure we can provide all necessary care and treatment in the safest possible way, at the right time and in the right place for our patients. Through this, we are making our pledge to you about the improvements we intend to make over the period 2023-24.
This report will tell you how well we performed against the quality priorities and goals we set for the period of April 2022 to March 2023 and the areas we have improved through this year. It will also detail the priorities we have agreed for the period of April 2023 to March 2024.
We will describe to you the areas where we have reviewed our patient care in order to evaluate the quality of services provided. This report will contain mandated information from our Board, along with statements from our commissioners and partners. We will also provide a glossary of terms.
Governance arrangements
Our Quality Account is prepared in line with the Quality Accounts toolkit guidance with additional information included in line with advice received by NHS England as follows:
y Details of ways in which staff can speak up (including how feedback is given to those who speak up), and how the trust ensures that staff who speak up do not suffer detriment
y A statement regarding progress in implementing the priority clinical standards for seven-day hospital services
y A statement that evidences an improvement plan to reduce rota gaps for NHS doctors and dentists (Schedule 6, Paragraph 11b of the terms and conditions of service for NHS doctors and dentists in training (England) 2016)
A draft of the report was shared internally with the senior management team members and two quality governance meetings for peer review, with external stakeholders at the Integrated Care Partnership, Essex and Hertfordshire Healthwatch and the Health Overview and Scrutiny committees for both Essex and Hertfordshire in May 2023. Where we received their responses, these are included within this report.
The draft Quality Account was presented to our Audit and Quality and Safety Committees (both subcommittees of Trust Board) for review in May. The document was presented to Trust Board in June 2023.
The final draft document was given delegated authority for members of the Trust Quality and Safety Committee to approve during the final week of June 2023.
Care Quality Commission rating
Figure 1: Our overall trust rating
The most recent inspection of the Trust completed by the Care Quality Commission (CQC) was an unannounced focused inspection over the summer of 2021, this included a review of the Trust wide Well-Led Key Line of Enquiry. The care services inspected were:
y Maternity care
y Medicine (including elderly care)
y Urgent and emergency care (emergency department)
The CQC report was published on 17 November 2021 and the ratings assigned to the Trust by the CQC are below:

4 5 5
A summary of the 2021 CQC inspection showed
The CQC identified areas where improvements had been achieved, these were:
y We appointed a director of midwifery to strengthen clinical leadership
y The sustainability of the medical rota in midwifery which has improved following the cohort of doctors that started in the summer of 2021
y Urgent and emergency care service leaders have made improvements in governance meetings
y The urgent and emergency care service have a good skill mix of staff on each shift and this is reviewed regularly. Consultants were supported by a team of junior doctors with the shifts overlapping at middle and foundation grades
y The Trust has systems and processes in place to learn from incidents, complaints and safeguarding alerts to drive improvements. This included utilising peer reviews and thematic deep dives
y All of our people are committed to continually learning and improving services. They are developing a better understanding of quality improvement methods and the skills to use them. The Trust is also enhancing its quality improvement
capacity
y Despite the challenges of the pandemic, the Trust continued to engage with people, patients and their representatives and system partners in an open and transparent manner
The CQC noted outstanding practice in relation to the Patient Panel:
y The Trust’s Patient Panel was the only model of its kind regionally.
The Patient Panel is a voluntary group whose main objective is to provide support for patients and their relatives/carers. The Patient Panel receive funding from the Trust to ensure patients’ voices are heard.
The panel was awarded the Queen's Award for Voluntary Service in July 2021.
The report detailed 29 recommendations for the Trust:
y 18 must do actions
y 11 should do actions
The recommendations were collated into individual projects and were updated by the relevant divisional teams, using our quality improvement methodology, to enable a consistent and sustained approach to the achievement of these objectives. Each project has a designated executive, a
senior responsible officer (SRO) and we have appointed a quality project management team to provide additional support.
We used a quality improvement plan as a dynamic document; with additional topics added over the year, as we identified areas that required further improvement. The quality improvement plan was monitored monthly through the clinical quality improvement group that reports into the Trust compliance group and onto the Quality and Safety Committee.
Immediate actions were implemented following receipt of the warning notice, with further actions underway. We were confident that the actions undertaken and planned in the coming weeks and months will ensure we improve the safety of patients in our emergency department.
Our people used the CQC inspection outcomes as the foundation upon which to critically examine our services and focus on how we plan and deliver the fundamental aspects of safe care. We have taken decisive action to change everyday activities, which have led to significant improvements.
Following this inspection, the CQC assigned the urgent and emergency care department (emergency department) a rating of inadequate in the domains of safe and well led. They issued a Section 31 warning notice that required initially weekly and monthly submission of data to them. During 2022, as a result of assurance provided from the submitted data, this was changed to monthly submissions.
Specific focused inspection of the urgent and emergency care department
The CQC completed an unannounced focused inspection of the emergency department in March 2023 to monitor our progress against the Trust action plan and review our performance
against their Key Lines of Enquiry standards.
In May 2023, the CQC sent the Trust a letter confirming that following their inspection and improvements against their previous concerns, they would remove the Section 31 warning notice. The CQC will publish their final report and update their website in due course.
The report was received in mid-June 2023 and we were pleased to note the CQC have improved the grading for the urgent and emergency department from Inadequate to Requires Improvement.
The CQC noted improvements that have taken place in the department for:
y Delivery of safe care to patients and the department, meeting the standards for leadership covering the area of Well Led
y The grade for the department overall has improved to meet the standard of Requires Improvement
y We are pleased that the CQC stated that we deliver outstanding practice for the provision of care for patients in a mental health crisis. We ensure a registered mental health nurse is rostered on every shift to meet the needs of patients and ensure timely risk assessments are completed
y The CQC have recommended three must complete actions and three should complete actions to be implemented. We are in the process of developing our action plan to address these areas.
Quality Account priorities for improvement during 2023-2024
Our seven Quality Account priorities for the next year are identified in line with the quality elements of our Trust objectives, which focus on our patients, our people, our performance, our places and our pounds.
Our patients and our performance
1. We will maintain the Trust Hospital Standardised Mortality Rate (HSMR) within expected and we will continue learning from every death. This will
6 7 7 Our overall ratings by service
Safe Effective Caring Responsive Well-led Overall Medical care (including older peopleÕs care) Requires Improvement Requires Improvement Good Good Requires Improvement Requires Improvement Services for children & young people Good Good Outstanding Good Good Good Critical care Good Good Good Requires Improvement Good Good End of life care Good Good Good Good Good Good Maternity Requires Improvement Requires Improvement Good Good Requires Improvement Requires Improvement Outpatients and diagnostic imaging Good Not ated Good Requires Improvement Good Good Surgery Requires Improvement Good Good Good Good Good Urgent and emergency services Requires Improvement Good Good Requires Improvement Requires Improvement Requires Improvement
improve quality of care for all patients.
2. We will continue to deliver high quality care in the right place and at the right time for our emergency and urgent care patients. This will be demonstrated through an improvement in our emergency department care.
Monitoring progress on our 2023-2024 quality improvements
1. Digital health

These priorities will be monitored using our existing governance structures; this will include being monitored through our Quality and Safety Committee.
3. We will reduce the proportion of complaints or patient advice and liaison service (PALS) concerns that detail communication as the main concern. We would like to see evidence from patients’ feedback that communication with them is improving.
2. Our new hospital
4. We will reduce the number of moderate and severe harms inpatient falls and to continue to learn from each of these incidents. This will improve quality of care for patients at risk of falls.
5. We will reduce the number of hospital acquired pressure ulcers resulting in moderate and severe harm and continue to learn from each of these incidents. This will improve the quality of care received by our patients at risk of developing pressure ulcers.
Our people
6. We will improve our people’s satisfaction, measured through the annual NHS Staff Survey. This will benefit the Trust through the improved wellbeing of our people.
Our places
7. We will continue to work in partnership to improve our hospitals and health infrastructure for our patients.
Our pounds
By improving the quality of care as detailed in the priorities above, we will deliver greater value for money for our patients.
Statements relating to quality of care provided PAHT is a 418 bedded hospital with a full range of general acute services, including; a 24/7 accident and emergency department (A&E), an intensive care unit (ICU), a maternity unit (MU) and a level II neonatal intensive care unit (NICU).

We serve a core population of around 350,000 and are the hospital of choice for people living in east Hertfordshire and west Essex. In addition to the communities of Harlow and Epping, we serve the populations of Bishop's Stortford and Saffron Walden in the north, Loughton and Waltham Abbey in the south, Great Dunmow in the east, and Hoddesdon and Broxbourne in the west. The extended catchment areas incorporate a population of up to 500,000. We own the main hospital site in Harlow, and operate outpatient and diagnostic services at Herts and Essex Hospital, Bishop's Stortford, and St Margaret’s Hospital, Epping. The operation of these facilities forms part of the longer-term strategy of bringing patient services closer to where people live and making services, where appropriate, that are more accessible and easily available to patients. We operate over 64 different services to meet the needs of our patients (see the service portfolio in table 1, overleaf).

8 9 9
Table 1: Directory of our services
Children and women's services
Antenatal and newborn screening
Children’s ward including patient at home (23/24 delivered by community provider)
Colposcopy and hysteroscopy services
Community midwifery
Clinical haematology
Dermatology
Interventional radiology Medical oncology
Dietetics
Infection prevention and control services
Early Pregnancy Unit
Foetal medicine
Gynaecology ambulatory service
Infant feeding support Newborn hearing screening Neonatal critical care – special care baby unit and neonatal community nurses
Gynaecology including termination of pregnancy services
Maternity: Antenatal clinics
Ultrasound scanning Labour Ward Antenatal Ward Postnatal Ward Maternity Assessment Centre (Maternity Triage and Day Assessment Unit)
Birth Centre Community midwifery services
Homebirth service
Maternity bereavement services
Specialist antenatal services
Obstetrics
Paediatric diabetic Medicine
Paediatrics – inpatients, outpatients, ambulatory care
Tongue tie service
Clinical support services
Audiology Blood tests
Breast surgery Chemotherapy
Mortuary and bereavement services
Neurology
Oncology services Outpatients Patient appliances Pathology: microbiology, cellular pathology, blood sciences, biochemistry
Pharmacy services Physiotherapy and occupational therapy
Tissue viability Transfusion services
Medicine
Cardiology Diabetic medicine
Radiology Speech and language therapy
Endocrinology
General medicine
Genito-urinary medicine Geriatrics including frailty Medical inpatient wards Older people's assessment and liaison (OPAL)
Oncology services relevant to medical care
Patient at home, adult (23/24 delivered by community provider)
Respiratory medicine
Rheumatology
Specialist palliative care and end of life services
Surgery and critical care
Day surgery Colorectal services
Ear, nose and throat Endoscopy services
Gastro enterology
General surgery High Dependency Unit
Intensive Care Unit
10 1111
(Anaesthetics and ICU) Surgery –inpatients Trauma and orthopaedics Urology Vascular services

Urgent and emergency care

Adult assessment services incorporating same day emergency care and urgent 'hot' clinics

Urgent Treatment Centre
The review of services and all associated data is undertaken through the Trust governance structure. This includes monthly meetings reviewing information covering patient experience and engagement, patient safety, learning from deaths, vulnerable patients and the Infection Prevention and Control Committee and bi-monthly Clinical Effectiveness and Compliance Groups. All of these groups report monthly into the Quality and Safety Committee, a subcommittee of Trust Board.
Review of each service's performance (Appendix 1) within the Trust has been monitored through the Performance and Finance Committee, with external review undertaken by both Essex and Hertfordshire commissioners at the monthly Service Performance and Quality Review Group.
Our achievements against the priorities we set for completion in 2022/23 Our patients
To reduce mortality, improve HSMR and improve our patients’ experience. Our patients:
1. Aim: We will maintain the Trust Hospital Standardised Mortality Rate (HSMR) within expected and we will continue learning from every death. This will improve quality of care for all patients.

Outcome: Not achieved - see below for the explanation
The Trust had shown a significant improvement in its 12-monthly rolling HSMR for the period of November 2021 –

October 2022 (see figure 1 below). However, for the period December 2021 – October 2022 the position deteriorated with an HSMR of 108.46 which is 'above expected'.
This is due to operational challenges leading to the submission of incompletely coded data. There are very few deaths in the uncoded superspells episodes of care, leading to an exaggerated impact of the number of deaths on both the in-month HSMR (May-September 2022) and the 12-month rolling HSMR, which can be seen in figures 1-3 below. It is anticipated that with the annual data refresh performed by the Hospital Episode Statistics team in May 2023 (reflected in the data available in July 2023), the mortality indices will return to ‘within expected’.
12 1313 Maxillo-facial surgery Ophthalmology Oral
Perioperative
surgery
Medicine
Clinical Medical Delivery Unit Emergency department Paediatric emergency department
Figure 1: HSMR 12 Month Rolling Trend
Figure 2: HSMR 12 Monthly Trend December 2021 – November 2022
Table 2 describes the percentage of patient superspells in hospital that were uncoded for the months of May to August 2022.
y From analysis completed by Telstra (previously called Dr Foster), there are very few deaths in the uncoded patient superspells.
y As a result, the impact of the uncoded superspells is greater with the effect of artificially exaggerating the impact of deaths on the mortality indices.
y It is anticipated that with the annual data refresh performed by the Hospital Episode Statistics team in May 2023 (reflected in data available in July 2023) the mortality indices will return to ‘within expected’.
Standardised Mortality Ratio (SMR)
The standardised mortality ratio (SMR) figures 4-5 have also been negatively impacted by the Trust coding position with the 12-month rolling SMR for the period December 2021 to November 2022 at 107.1, which is 'above-expected'.


In summary:
y The likely cause for the deterioration in our mortality indices is the submission of incompletely coded data due to operational challenges
y Completed data had been submitted by the HES freeze date from the month of September 2022 onwards
y It is anticipated that with the annual data refresh performed by the Hospital Episode Statistics team, the 12-month rolling HSMR and the in month HSMR figures for May-September will return to ‘within expected’

Learning from deaths does not rely on the mortality indices. The following processes complement the mortality data:
y The Telstra data set includes diagnosis-specific mortality outliers. All of the patient deaths within each outlier group are reviewed by the clinical specialty leads and the coding leads

y All deaths are scrutinised by the medical examiner team
y 25% of deaths are further reviewed using the structured judgement review approach and learning shared through monthly departmental mortality and morbidity meetings.
y Any concerns raised through or external to these processes are scrutinised by the incident management group by reporting using the Trust Datix system
y Regional networking has commenced, in order to improve learning and benchmarking for national and local processes
y The SMART database was implemented in July 2021 and is fully embedded at the Trust
y This is used for the completion of Medical Examiner independent reviews and s well as Structured Judgement Reviews
y The database produces a mortality dashboard, which can be filtered to individual specialities or divisions. This allows teams to review mortality over defined periods of time
y This has proved a useful tool in pulling themes and trends in order to understand the Trusts mortality status and where improvements may be required
Next steps:
y The Trust is currently recruiting within the coding department
y Training is ongoing for clinical staff on the importance of accurate documentation and the impact this has on the Trust's clinical data quality
y An associate medical director for mortality and risk has been appointed to support the mortality programme
y Preparation for the implementation of the national medical examiner reporting system is underway
y Enhanced networking with regional peers for benchmarking purposes is being undertaken
y Improved networking with primary care providers is being supported in order to share learning across the system
14 1515 Figure 3: HSMR Rolling Trend December 2019 – November 2022
Table 2: Residual codes as activity – single month position for the last 12 months
Figure 5: SMR Rolling Trend December 2019 – November 2022
Figure 4: SMR Monthly Trend
Our patients
2. Aim: Continue to deliver high quality care in the right place and at the right time for patients attending our emergency and urgent care departments. This has been demonstrated through the removal of the CQC Section 31 notice and an improvement in our emergency department. For our patients, this will improve the quality of care and experience.
Outcome: Partly achieved


Urgent care and emergency department performance
The urgent care attendances during the year have seen sustained high numbers coming to the Trust. In 2022/23, Covid-19 infection fluctuations have not significantly impacted attendances.
y The separate respiratory emergency department was maintained throughout the year until the winter when additional capacity in the main department was added


y A separate area for the Urgent Treatment Centre was maintained and expanded. There are additional separate areas for patients requiring blood tests and physiotherapy
y All walk-in patients are streamed to the most appropriate emergency service,
enabling the emergency department to concentrate on the most urgent cases

y In the summer of 2022, the emergency department implemented an Electronic Health Record system which enables clinical triage on first attendance and streaming of patients to the most appropriate location for their care, which is a significant safety improvement.
y The ongoing waves of COVID-19 admissions and increased pressures in the wider health and social care system have increased the flow of patients through the hospital and subsequently returning to home and care settings, figures 6-7
y As a result of ongoing demand, the bed occupancy has continued to be high which then impacts the time to admission on a ward and the ambulance handover performance
y Over the winter 2022/23, improvements were implemented to decrease the time patients waited in ambulances

y The standard to ensure patients are treated, discharged or admitted within 4 hours of arrival in the emergency department has been below the national standard for the year
y An extensive recovery programme is in place
We have continued to work with our system partners to further develop streamlined services that can be delivered in the most effective location and to prevent attendances and admissions to hospital.
y This has resulted in increased intermediate care capacity, patient at home support for patients with existing care packages and sharing of staff.
y This collaboration has been essential to support the various services across the wider health and social care system.
y The Trust has continued to focus on reducing long length of stay for patients through collaborative work with the ICS and further initiatives are in place for 23/24 to improve timely discharge of patients to their home setting.
Our people
3. Aim: We will improve the health and wellbeing of our people, offering a wide range of support, so that every member of staff can recover from the effects of working during the pandemic, can stay well and feel they can meet the demands of their roles. Measures of success will be:
y Improved staff health and wellbeing scores from 5.5 to 5.7

Outcome: Partially met and remains ongoing In 2022/23, we improved our staff health and wellbeing scores in the NHS Staff Survey.
y Our scores in the year improved up to 5.6
y Within the Staff Survey, the People Promise section relating to 'we are safe and healthy' stated that we have a safe and healthy culture, which scored the same as last year
y Overall the score for Question 11a, 'my organisation takes a positive action on health and wellbeing', stayed at 50%, which was the same as last year’s scores.
16 1717
Figure 6
Figure 7
Our people
4. Aim: We will complete an annual report to review the doctors' rota gaps for those in training roles. This will help with planning of rotas and services in the future.
Outcome: Not achieved
The Trust has commissioned an external review of our medical rotas to cover establishment and activity.
The review will consider 12 weeks of data and we anticipate receiving the findings in mid-July 2023. This will then be presented through the people governance structure.
Our performance
Quality improvement projects in order to transform services are working to modernise how delivery of care and timeliness of treatment and patient experience can be improved.
5. Aim: Outpatient improvement programme: We will continue to transform outpatient services to meet both the needs of our patients and the NHS Long Term Plan. This includes use of technology and the redesign of our services to enable timely and appropriate consultations for our patients.
Measures of success will include improved patient experience gained through their feedback, and through reduction in patients not attending booked appointments, reducing the number of follow-ups and improvements in timeliness of clinical treatment.
Outcome: Achieved
Patient initiated follow up (PIFU)
y This pathway allows patients to determine whether their condition requires clinical intervention and allows access to a specialist when needed. In turn this reduces the number of follow up appointments needed
y This pathway is now available to all
clinical specialties and approximately 7,000 appointments have been saved. Fracture clinic, neurology and physiotherapy have all exceeded their 5% target for PIFU
y Plans are being developed for extending this target in 2023/24 to explore further the use of this pathway for those patients who are admitted into hospital rather than automatically booking an outpatient appointment for review
Long term condition – patient managed pathway
y This pathway allows our patients with long-term conditions, who cannot be discharged from hospital care, to determine when their condition requires clinical intervention allowing rapid access to a specialist when needed
y A pilot is about to go live within our gastroenterology service for those patients with inflammatory bowel disease (IBD). Separately patients requiring the Breast Cancer Surveillance and those with Multiple Sclerosis (MS) will then follow as part of the pilot
y Following the pilot project this pathway will be rolled out across groups of patients with appropriate conditions with a planned completion date by June 2024.
Our performance
6. Aim: Theatre transformation: We will continue to ensure that all perioperative resource, including staff are used effectively and efficiently to deliver highest quality patient care. Measures of success include reduced waiting times and COVID-19 related backlog. This will improve patient experience and quality of care. It is planned that robust theatre scheduling principles will be implemented to include improvements to the start and finish times of theatre lists, leading to improved theatre utilisation. These plans are all measurable, so that success can be proven.
Outcome: Achieved
Theatre Dashboard
y Theatres efficiency programme was launched with service leads
y A dashboard has been developed and is now live
y Twice monthly project meetings are in place
y The project scope has been agreed
y High level milestones are in place
6-4-2 process to book theatre slots
y High level milestones have been agreed
y Scope of project agreed and project leads are monitoring progress
y Ongoing project meetings planned and taking place
Pre-op assessment
y High level milestones have been agreed
y Scope has been finalised and project leads are in place
y Ongoing project meetings planned and are taking place
Our performance
7. Aim: Medicines optimisation: We will continue to ensure that patients are involved in the decision-making about their medications and that they receive the correct medications at the right time. Measures of success will include fewer harms to our patients, improved patient safety, reduced waste caused by unnecessary prescribing of medications leading to an improvement in patient safety. It is planned that an antibiotic dashboard will be implemented and divisions will introduce a robust model for reviewing compliance with antibiotic prescribing policy, to include the ongoing development of the antibiotic review panels.
Outcome: Achieved
Medicine’s Optimisation
Antibiotic Stewardship
y Further development of an antibiotic dashboard that identifies antibiotic prescribing habits throughout the
Trust
y The data from the dashboard is being utilised within divisional performance review meetings
y Ongoing development of tests of change supporting the ongoing reduction in antibiotic usage across the Trust
STOP IT
y STOPIT supports pharmacists and doctors to systematically review continuing medication in individuals who come into hospital with medicine related problems
y The STOPIT process is currently embedded on a number of wards throughout the Trust
y The pharmacy team are working further within other divisions to embed and adapt the process throughout the Trust
Venous thromboembolism (VTE)
y Implementation of a VTE dashboard to support the development of further monitoring so that related improvements can be evidenced
y Development of an automated breach report is in place, to support improvements in patient safety
Our places
Improve our clinical areas and critical functions
8.Aim: We will continue to work in partnership to improve our hospitals and health infrastructure for our patients.
Outcome: Achieved
The funding for a new hospital has been announced and approved. A build schedule will be agreed and set. The need for a new hospital for the local area is well established and will serve local people for years to come. It will also provide the best place to work for our clinical and corporate teams and enable us to make a real difference to healthcare in our community and will appeal to new people to join PAHT.
18 1919
Our people have worked in partnership to provide the lead role in bringing part of the Government plan to increase diagnostic care in the community to our local patient population. We are the project lead for a new diagnostic hub planned to be at the St Margaret’s Hospital in Epping. This will provide additional scanning and diagnostic testing at the weekend and longer opening times during the week. The hub will have a partner diagnostic spoke based at Herts and Essex Hospital in Bishop’s Stortford. This development brings diagnostic tests closer to patients, increases the number of appointments and extends the days of the week that tests are available, which will support local people.
This year, we have refurbished areas of our current estate to continue to provide a safe environment for our patients
and our people. We have developed plans to enable improvement of our Maternity Unit, which will be extended and enhanced to give a better space. This will improve the clinical offering and the health and wellbeing of the people choosing PAHT to have their babies.
The implementation of our new electronic health record (EHR) is set to be well underway and being tested in the next 12 months, prior to a planned go live in autumn 2024. The project team is being established and these dedicated digital experts will bring the energy, enthusiasm and drive to embed the new patient records system across the organisation. The significance of this improvement cannot be underestimated and will bring confidence and efficiency to the way our people deliver care to our patients.
Our patients
Infection prevention and control (IPC)
COVID-19
We are in a better place nationally and locally with regard to COVID-19 than we have ever been since early 2020, and many believe the pandemic is behind us. However, reality compels us to offer solutions to bring our patients and staff along to a new, non-emergency phase of the pandemic with a changing picture monthly.
Throughout 2022, there was a notable reduction in patients developing severe illness with the Omicron variant. COVID-19 hospital admissions continued to fall as the months passed, and demonstrated that vaccines provided strong protection against severe illness and death. Increasing numbers of our hospital inpatients testing positive for COVID-19 were asymptomatic.
The UK Health Security Agency (UKHSA) advised that the NHS should plan for a response to all the common respiratory viruses including COVID-19, Influenza and Respiratory Syncytial virus (RSV). As people mixed more, nationally and locally we saw increasing levels of other infections such as Influenza, RSV, Norovirus and Group A Streptococcal disease. Influenza vaccination was encouraged in vulnerable people to reduce influenza and COVID-19 coinfections.
COVID-19 tests continued to be routinely used as part of a diagnostic pathway for symptomatic patients and staff. Increased access to treatments for COVID-19, and high immunity levels amongst the population (due to natural infection and/ or vaccination), has allowed a scale back of testing in England for the public, and in hospital for emergency admissions, the elective pathway and transfers of care. Asymptomatic testing in our hospital patients and staff gradually reduced throughout the year. After April 2023, lateral flow tests (rather than Polymerase
Chain Reaction - PCR) will be used for care home discharges.
Local discretion is being encouraged in Trusts, with a gradual reduction after the winter of 2022/2023 for return to work protocols for COVID-19 positive staff, and testing of immunocompromised patients. Use of fluid-resistant surgical masks (FRSMs) will be advised from April 2023 only in respiratory wards and selected high risk settings. Individual choice for mask use by staff and patients will continue in other settings.
Application of national IPC guidance (from NHS England and/or the UK Health Security Agency) and robust risk assessments continued to be central to recommendations made by the Trust Infection Prevention and Control (IPC) Cell. We are fully compliant with national IPC manual recommendations for England (introduced in April 2022). IPC strategies were supported by the Trust Board with a Board to ward approach.
y Point of Care (POC) testing continued throughout the 2022/2023 year, and complemented our in-house PCR testing protocols
y A respiratory winter plan was developed with segregation of cases of the various respiratory viruses, in isolation rooms or bays whenever possible



y Regular reviews of COVID-19 protocols took place in relation to use of fluid resistant surgical masks (FRSMs) in clinical and non-clinical areas, and risk assessment of personal or work environments
y Filtering Face Piece (FFP3) mask resilience was improved by our trained IPC associate team. They will continue with this work in 2023
y Nosocomial infection was managed. 246 of 670 nosocomial cases were noted to be asymptomatic infections. There were 41 Covid-19 nosocomial outbreaks during the year
y Evaluation of ventilation, including alternative technologies continued
y The IPC Cell and IPC Committee met regularly all year and reviewed reports
20 2121
on hand hygiene, personal protective equipment (PPE) donning and doffing, IPC training, and cleaning standards and decontamination
y The IPC Board Assurance Framework was kept under regular review
y National guidance on visiting was implemented. Compassionate visiting (e.g. end of life) and visits from other care givers was supported
y Staff testing protocols, implementation of a staff vaccination programme for COVID-19 and Influenza, and monitoring staff illness/absence/ wellbeing continued to be supported by staff health and wellbeing (SHaW) and our people team
y National testing protocols with lateral flow tests or PCR prior to elective procedures remained in place
y Staff were supported in adhering to IPC policies for control of COVID-19 and other alert organisms, and during outbreaks of infection
y Integrated Care Board (ICB) and public health engagement (from the consultant and lead nurses in public health, Essex Health Protection Unit) with the IPC team occurred on a regular basis, and formally at the monthly IPC Committee
Influenza and other respiratory viruses
Testing for Influenza A and B, COVID-19 and Respiratory Syncytial Virus (RSV) has been undertaken this year for respiratory paediatric admissions and in adult respiratory wards as part of our 2022/ 2023 winter plan.
There were very few COVID-19 and Influenza co-infections in our patients. The number of Influenza A cases detected in adults significantly increased in December 2022, but there were very few outbreaks or transmissions as a result of this.
Between December 2022 and January 2023, an increase of adult RSV cases occurred, but much less than Influenza case numbers. A decision was made by January 2023 to discontinue
Point of Care (POC) tests for routine
management of respiratory viruses in paediatrics, as it was more cost-effective to use laboratory PCR tests as and when required.
Challenges for access to side room isolation capacity continued throughout the winter months.
Clostridiodes difficile (C.difficile)
A total of 36 C. difficile cases were reported during the year 2022-2023 (below the threshold of 56 cases), as shown in the C.difficile table, figure 8, overleaf. Of these, 28 were hospitalonset, health care associated (HOHA) detected three or more days after admission. Eight were community-onset healthcare associated (COHA) detected in the community or within two days of admission to hospital, and the patient had been an inpatient in the Trust in the previous four weeks. This compares with a total of 35 cases in 2021-2022, 18 of which were HOHA, and 17 were COHA.
Cases were reviewed as part of the root cause analysis (RCA) process at the bi-monthly Incident Review Panels, identifying any trends/themes and sharing of learning. Panel reviews include the monitoring of key IPC measures for the control of C.difficile including isolation, sampling, cleaning, hand hygiene and the prescribing of antibiotics.
The total antibiotic consumption in the organisation was noted to be high and, as such, there has been a strong focus on antimicrobial stewardship (AMS). Oversight and monitoring of antibiotic usage continued through the monthly Antimicrobial Stewardship (AMS) Group meetings, working with medical and pharmacy colleagues in the monitoring of antibiotic consumption. Adjustments were made to the Trust antibiotic policy, including the introduction of new antibiotics (e.g. Temocillin) which are known to pose a low risk of C.difficile.
In view of its high prescribing of antibiotics, the Trust requested an external peer review to be undertaken
by our regional NHS England (NHSE) pharmacy and IPC colleagues. Positive feedback was received and the Trust have been working through an action plan. However, it has since been observed that there may be some data errors in relation to antibiotic consumption, which is currently being reviewed.
The threshold target for 2023-24 has been set at 34. Control of C.difficile remains a top priority for our clinical teams, the IPC Committee, and the Antimicrobial Stewardship Group in 2023-24, as well as for the region.
cases by month



MRSA Bacteraemia
There were no cases of HOHA or COHA MRSA bacteraemia this year, meaning the Trust achieved the zero-tolerance trajectory. In December 2022, a patient with a community onset, community associated (COCA) bacteraemia was admitted; the patient had not had any association with PAHT and was therefore investigated by the IPC team within the Integrated Care Board (ICB).
MSSA
Unlike with other organisms, there is no trajectory in place for MSSA bacteraemia, however, the Trust has continued to closely monitor and review its cases. The Trust has previously had a low rate of MSSA bacteraemia cases. Over the last couple of years there has been an increase, however, the Trust is in a similar position to other Trusts in the region, and to the East of England regional average rate per 100,000 occupied bed days.
There was a total of 15 HOHA and four COHA cases in 2022-23 (as seen in figure 10, below), which is similar to the case numbers in the previous year. Cases are reviewed as part of the IPC Incident Review Panels. Subsequent to some of the RCA findings, work is in progress to improve intravenous line care throughout the Trust, which has included implementation of an upgraded cannula, and an E-Learning training module for all staff involved in cannulation.
22 2323
Figure 8: C.difficile cases 2022-2023 –
Figure 9: MRSA Bacteraemia cases 2022-23
Bacteraemia
Figure 10: MSSA Bacteraemia cases 2022-2023
Gram Negative Blood Stream Infections (GNBSIs)
There is a whole health-care economy ambition for reducing healthcare associated GNBSIs by 50% by 2024/2025, particularly E.coli BSIs, which represent the highest number of all Gram-negative bacteraemia cases. Thresholds for GNBSIs were assigned to individual organisations for the first time in July 2021. The thresholds allocated to the Trust are at the lower end, compared to those for other Trusts in the region. For E.coli and Klebsiella species, the Trust is slightly above its thresholds, but is similar to the regional average (and a similar number as in the previous year). Pseudomonas aeruginosa is below the Trust threshold, and below the regional average rate. the Trust is below its threshold, and again, an almost identical position to the previous year. It is known that the COVID-19 pandemic had an effect on the increase of health care associated infections, including bacteraemia infections; this is being monitored.
The Trust has developed a process for a more robust review of GNBSI cases to be reviewed in 2023-2024 – this will ensure any trends/themes are identified, enabling any learning to be shared, and improvements to clinical practice where required.


Figure 11-13: Gram Negative Bacteraemia cases 2022– 2023



Infection incidents and outbreaks

Norovirus
There were five outbreaks of confirmed norovirus in the Trust during 202223. Norovirus is a common cause of diarrhoea and vomiting outbreaks in hospitals (and other close contact settings) during the winter months. Incidences have risen at this time nationally, most likely because people are now having more contact again and reducing IPC precautions in the community.
Mpox (previously called Monkeypox)
During May 2022, Trusts were notified by UKHSA of several cases of Monkeypox, a rare infection, most commonly found in west or central Africa, identified in the UK. Within the Trust, two confirmed cases
of Mpox were identified (not patients that were admitted) and managed appropriately in the community. Several more suspected cases attended the emergency department (ED) during this period of increased prevalence (all negative). The IPC team had robust processes and guidance in place, working with clinicians in ED to support and manage cases.
Group A Streptococcus (GAS)
During the winter months of 2022-23, there was a national increase in lower respiratory tract Group A Streptococcus (GAS) infections in children and adults.
GAS can cause severe illness and, unfortunately, mortality in a small number of cases. There was no evidence that the rise in cases was linked to a new strain, the increase most likely related to high amounts of circulating bacteria, possibly
through increased social mixing and a higher number of other respiratory viruses in circulation.
Locally, the number of GAS isolates from all clinical samples received from the community, was higher than normal from April 2022, and significantly higher from December 2022 in children under 16 years old. In adult cases, an increase was observed from December 2022, reflecting the national prevalence data, where a rise in cases in those over 65 years has been identified.
The increased incidence of GAS infections primarily impacted on our paediatric emergency department (ED). The ICB undertook a number of actions, including the setting up of GP hubs, in order to facilitate the management of GAS infections in the community. This resulted in a reduction of attendances to ED. Despite the rise in the number of GAS infections, the number of patients requiring admissions was low. Although there were confirmed cases of invasive GAS, numbers were low, but with serious outcomes for some patients.
The impact on IPC measures (e. g. side room allocation) within our inpatient areas was minimal. The situation will continue to be closely monitored.
The Trust has a robust quality governance process in place for monitoring infection rates and trends. These are shared with each division on a monthly basis and details compliance against IPC audits, testing compliance and is reported through the Infection Prevention and Control Committee. Each division participates in this group, thus ensuring that services will be able to disseminate learning throughout our clinical teams. Information on trends, themes and learning identified as well as the detail contained in this section is reported monthly to the Trust Board. subcommittee called the Quality and Safety Committee.
Conclusion
As the year comes to an end, we continue to follow the national steer to manage COVID-10 infections along with other respiratory viruses, in line with recommendations in the national IPC manual, which was published for the first time in England in April 2022.
In addition to COVID-19, we continue to monitor other organisms including group A streptococcal infections, responding to these infections to inhibit spread, and continuing to maintain nationally recommended IPC practices.
24 2525
Quality improvement
At The Princess Alexandra Hospital NHS Trust (PAHT), we define quality improvement as: ‘Working together in partnership to make the sustainable changes that will lead to excellence for our patients, people, places, performance and pounds'.
Quality First team (Quality Improvement and Programme Management Office)
The Quality First team includes both the quality improvement team and the programme management office. Together, we are dedicated to working alongside our people, patients and wider health and care partners, to ensure that everyone is equipped and enabled to deliver quality improvement and transformation.
Quality improvement (QI) team
We inspire our people to put quality first for the benefit of our patients, staff and wider community. We achieve this by developing capability, strengthening confidence and enabling capacity to support and guide the organisation through continuous improvement and to achieve our strategic priorities, namely
PAHT2030. The quality improvement team has two key functions:

1. Lead PAHT’s Improvement Partnership, we build our people’s confidence and capability in delivering quality improvement and transformation.
2. Centrally coordinate and facilitate for the delivery of quality improvement and transformation programmes and projects that:
y address significant risks in the organisation
y support the delivery and realisation of strategy, namely PAHT2030
The Improvement Partnership
The Improvement Partnership is our primary method of achieving our purpose. The Improvement Partnership is the approach to enrolling, engaging, involving and developing our staff in quality improvement and transformation. This aims to flatten hierarchies (encourages and enables change agency), helping to give everyone a voice, and bringing our people and our patients together to improve and redesign the way that care and services are provided.
The Quality First Team currently delivers Leading Change and Leading Projects learning and development sessions with the objective of growing the confidence and competence of our staff to enable them to deliver successful quality improvement and transformation projects. When a quality improvement project (capturing project outcomes in a poster) is completed, the member of staff become a PAHT Improvement Partner.
The Improvement Partnership, launched in 2017, is our approach to enrolling, engaging, involving and developing our people in quality improvement and transformation. The Improvement Partnership aims to flatten hierarchies (encouraging and enabling change agency), helping to give everyone a voice, and bringing our people and our patients together to improve and redesign the way that care and services are provided. The Trust has over 500 people who have completed our leading change training and 200 have completed leading projects training. The Trust is proud to have 120 staff who are improvement partners. Now, more than ever, this is important to help ensure we achieve the strategic aims and objectives outlined in PAHT2030.
2022/23 programme highlights
The following outlines some of the projects and programmes that the quality improvement team have supported during 2022-23.
Improving patient outcomes (mortality improvement)

There were three key drivers for our sustained improvement:
y Recording, documentation and coding of care (accuracy and depth of coding)
y Activity changes, increase in days 0-1 on length of stay activity
y Improvements in quality of care (such as introduction of care bundles and improvements to hospital at night)
Learning from deaths software and mortality dashboard
y The ongoing development of an automated learning from deaths dashboard with SMART software including dashboards to better target our improvement efforts
Aspiration pneumonia
y Launch of shallow screening tool pilot for Older Person's Assessment and Liaison (OPAL)
y Development of a number of patient leaflets including modified diets and fluids, risk of feeding
y Mouth care audits in partnership with ward-based teams to target improvement efforts

Fractured neck of femur
y Improved the time it takes for this cohort of patients to be transferred from the emergency department to Tye Green Ward (our dedicated fractured neck of femur ward)
y This included early identification of patients, including use of a ‘femur fracture alert on our Trust wide bleep system, Alertive, to ensure fast track transfer of these patients to the ward
Acute Kidney Injury (AKI)
y Providing ongoing training and awareness, with deep dives into all cases where a death of a patient has occured due to an Acute Kidney Injury (AKI) were identified to determine if learning was required
y Ongoing development of a Trust e-referral for renal patients
Sepsis
y Providing ongoing training and awareness with deep dives into sepsis
y Deteriorating Patient Group has been re-established
y Funding agreed for a sepsis and AKI lead nurse
y Ongoing development of a sepsis digital assessment for both adult and paediatric patients to support their treatment using the sepsis 6 screen protocol

26 2727
Remote patient monitoring
y Implementation of a remote monitoring pilot on the respiratory ward to increase the frequency of patient monitoring at the bedside by capturing vital signs monitoring in real-time. The system uses an automatic early warning score calculation to improve accuracy and automates a cascade escalation to recognise and rescue deteriorating patients
Outpatients
Patient initiated follow up (PIFU)
y This pathway allows patients to determine whether their condition requires clinical intervention or access to a specialist for review when needed. In turn this reduces the number of follow up appointments needed
y This pathway is now available to all specialties and approximately 7,000 appointments have been saved since its introduction as a pilot in 2021. The services of fracture, neurology and physiotherapy are all exceeding the 5% target for patient initiated follow up
y Plans are being developed for 23/24 to explore further the use of the pathway for those patients who are admitted into hospital, so rather than automatically booking a follow-up outpatient appointment for a review, the patient will determine if this is required
Long term condition – patient
managed pathway
y This pathway allows our patients with a long-term conditions, who cannot be discharged from secondary care, to determine when their condition requires clinical intervention, allowing rapid access to a specialist when needed
y The pilot for gastroenterology is about to go live for patients with Inflammatory Bowel Disease (IBD)
y The next conditions to be rolled out onto the pilot are for breast cancer surveillance and Multiple Sclerosis (MS) patients
y Following these pilot programmes, this pathway will be rolled out across all appropriate conditions with a planned
completion date in Q1 2024
Medicines optimisation
Antibiotic stewardship
y Further development of an antibiotic dashboard that identifies antibiotic prescribing habits throughout the Trust. The data from the dashboard is being utilised within divisional performance reviews. Ongoing development of tests of change supporting the ongoing reduction in antibiotic usage across the Trust
STOP IT
y STOPIT is a programme to support pharmacists and doctors to systematically review continuing medication in individuals who come into hospital with medicine related problems. The STOPIT process is currently embedded on a number of wards throughout the Trust. The team are working further with teams to embed and adapt the process throughout the Trust
OUT Improvement Programme to support discharge
y Implementation of the SAFER Patient Flow Bundle ‘to make maximum use of capacity within acute care settings to support patient safety
y Criteria led discharge - Embed criteria led discharge (CLD) in to practice across our inpatient wards, implementation of a pilot process on the respiratory ward. To improve patient and staff experience
y Site team and transport – Development of a standard operating procedure to facilitate the establishment of a new discharge lounge including changing the skill mix of the staff
y Integrated discharge – Moving from <30% to >80% SRF form first time acceptance has demonstrated improvements in quality as a result of training and targeted feedback
y Care Coordination Centre (CCC) and Virtual Ward. Pilot work with the Integrated Discharge Team to establish proof of concept for discharge pathways that enable a move from a push to a pull model for pathways 2
and 3. Working with virtual ward team to support a new way of working
y TTAs – Implementation of a portering service to support earlier discharge on the wards
Nerve centre ED module
y Implementation of the Nervecentre Emergency Department (ED) electronic health record, providing a dedicated solution in both our adult and paediatric ED. To support improving patient safety, patient experience and patient outcomes. The module and functionality enable us to address concerns raised by our clinical staff and by the CQC in repeated reports
y Moving from three ways of documenting patient information in ED to one single solution which releases time to care for staff, avoids duplication of documentation and will help to ensure patients are seen within the national four-hour standard. The solution enables swifter assessment, treatment and departure of patients. Teams will also have better visualisation and oversight of patients, improving patient prioritisation and flow
Patient and clinical administration
To deliver a patient and clinical administration function that is modern, integrated and outstanding (PAHT2030) by:
y Embracing digital solutions where possible, to reduce duplication and human error
y Provide efficient and effective care for patients and an enhanced experience for our people
y Between August and September we ran a series of listening events (workshops), gathered responses via a survey and attended the Medical Advisory Committee (MAC) to inform the development of a ‘to-be’ operating model to provide efficient and effective care for patients and an enhanced experience for our people
General Medical Council (GMC) improvement programme
y Development of a programme to comply with the General Medical
Council (GMC) and Health Education
England (HEE) standards and requirements for the delivery of all stages of high-quality medical education and training. In addition, to support an improvement in the experience of our trainees to positively influence the results of the GMC survey to ensure we benchmark nationally at average or better
y Supporting quality improvement within this programme around resuscitation trolley components, the PAHT ‘too tired to drive’ policy, creating a standardised approach to local departmental induction, conducting listening events and supporting a process for the escalation of clinical concerns
Clinical strategy
y Programme of work developed including workshop template to support teams to progress their clinical strategies into delivery plans
y The first delivery plan workshop was held in March 2023 for paediatrics and received positive feedback from all involved
y The majority of our clinical strategies need to be approved by May 2023 via divisional boards and we will be working with specialities to develop these into delivery plans by quarter two (Q2).
The Programme Management Office (PMO)
This function was established in October 2021. The purpose of the PMO is to ensure there is an effective framework for the management of project deliverables to ensure sustainable change is implemented and that benefits are identified, managed, monitored and ultimately realised in a timely manner. The key deliverables and functions of the PMO can be broken down into the following areas: communication, reporting, programme management, monitoring, provision of tools and guidance, governance arrangements, risk management, challenge and support, facilitation, gateways, and delivery framework.
28 2929
Patient experience
The patient experience team set some local goals to be achieved during the period of 2022/23. The first was to increase PALS activity (providing speedy resolution to concerns raised). This has been achieved: with an increase of 13% in year with 4,248 PALS complaints in 2022/23, increasing from 2021/22 (3687).
The third goal was to reduce the instances of PALS concerns being escalated to formal complaints (providing assurance that issues are dealt with appropriately and in line with the Trust’s local complaint policy). This has been achieved with a decrease in escalations of 28% in year with 52 PALS cases escalated in 2022/23, a decrease from 67 in 2021/22.
The second goal was to increase the number of compliments received (indicating we are providing complimentary care to our patients). This has been achieved with an increase of 70% in year with 949 compliments received in 2022/23, an increase from 559 in 2021/22.
Whilst increasing the volume of PALS concerns, and reducing the amount of cases escalated from PALS, the patient experience team have maintained a steady volume of complaint cases (confirming that cases are being processed appropriately first time). 259 formal complaints were received in 2022/23, against 260 received in 2021/22.



The team also aim to acknowledge 95% of complaints within three working days. This was achieved. There were a very small number of cases where this was not achieved formally whilst the team either deliberated on how best to process the concerns, or at times of staff shortage versus volume of queries received. In all cases where formal acknowledgement was not sent, the complainant would however have received the automatic reply via email confirming their communication had been received.


30 3131
Figure 14: PALS received
Figure 15: Compliments received
Figure 16: Complaints from PALS
Figure 17: Complaints received
Section 18 Report
Every year, the Trust must make a statement under the NHS Health and Social Care Act 2009 about how many complaints it has received, their subject, the issue they raise, whether or not they were well founded and any actions taken. The Trust can confirm we received 259 complaints in the period 2022-23.
Subjects of complaints
The most frequently occurring themes were nursing care issues (220), medical care expectations (173) and communication (168).
Sub-subjects of complaints
The five most frequently occurring sub-subjects, specific issues raised within complaints about nursing care, medical care or communication, were as follows: lack of information to relatives (53), generally poor medical treatment provided (43), poor standard of nursing care (41), missed diagnosis (32), and inadequate treatment provided (30)
How many were well founded
In the language of the complaint’s services, the terminology used states whether or not the complaints are upheld. The vast majority (91%) of complaints are fully upheld or partially upheld. By this we mean that at least one of the concerns raised by the complainant required concerted action on the part of the hospital to address the issue, 84 were partially upheld, 2 upheld and 8 not upheld of those closed by the end of the financial year.
Actions taken
Actions are taken over the year and should demonstrate a clear connection from the concern raised to the change the organisation has made. Some of these are listed below, beginning with general actions, then actions in the form of case studies, explanations of how the Trust responded to specific complaints.
Case one:
A patient with Down’s syndrome presented to the emergency department
following injury to their knee, and was subsequently admitted under the surgical division for investigation and manipulation. The patient’s mother felt that the patient’s overall care did not take her additional needs into consideration.
Action plan:
y Complaint has been shared across surgery and urgent care divisions, with a focus on communication and the lack of conversation with the family to understand specific requirements of patients with additional needs
y Information on the Oliver McGowan training (disability and autism training available for NHS staff) shared with the patient’s family
y Actions are underway to make a video with the patient and their family, which can be shared Trust-wide to focus on the patient’s experience and how this made the patient and family feel. Additionally, the difference that good communication makes, ensuring the specific requirements for patients with additional needs are discussed and explored
Case two:
An elderly patient who was living with dementia attended the emergency department on the advice of their GP due to low sodium on a blood test. Their daughter was concerned about the level of care provided to the patient on the ward and the lack of information gleaned from or shared with the family.
Action plan:
y Improve communication between ward teams and patients’ families:
y Improve timeliness with regard to answering phones; by providing portable phones to ward teams to support answering outside of ward clerk core hours
y Increase visiting hours to support patients' next of kin being present at the time of medical reviews to improve communication
y Introduce matron/ward manager dropin sessions for families to meet the
senior ward nursing team to allow for immediate resolution of concerns
y Ensure ward teams comply with the latest infection prevention and control guidance and provide correct information to patients and their relatives. The ward manager is to share the latest guidance with the ward team and make sure this is displayed in the ward
Case three
A patient’s grandchild reported that their grandparent experienced a high standard of care throughout their stay. The clinical teams worked extremely hard to ensure the patient was well cared for. The hospital staff communicated clearly and liaised with the family to provide the best treatment, and were open and honest when the patient contracted COVID-19 and had a fall during their stay. However, the patient’s discharge was stressful and chaotic and resulted in a longer hospital
Patient Panel
Our Patient Panel were as active as ever this year, continuing with usual activities and taking advantage of new ways to meet using Microsoft Teams. Our Patient Panel continued to meet monthly and several members participate in the Complaints Reference Group.
Our panel members represent patients at many of our Trust committees and meeting groups that cover topics such as inpatient falls, end of life care, medicines management, patient safety and quality, research, digital senate, infection prevention and control, organ donation and nutrition.
Ann Nutt, chair of the Patient Panel, attends regular meetings with the Trust chair and chief nurse, conducting ward and clinical area visits, and liaises with many external groups and organisations. Diane Deane-Bowers, vice chair of the Patient Panel, represents the panel at the Trust’s Digital Senate, which is mapping out how patient data is to be digitally captured and made accessible in both acute and primary care settings.
The panel continue to actively work on the New Hospital Programme (NHP) work
stay and additionally a rushed discharge over a weekend.
Action plan:
y Transfer of care team to lead on delivering discharge training to the therapies and ward team
y Dementia training to be considered for future training sessions for all staff involved in discharge
y Access and availability of social work team to be communicated to the therapies team

y Leaflet on discharge services to be available on all wards for patients and next of kin
y Clear guidance to be provided for telephone and face to face meetings with family with predetermined agenda
y Nursing issues regarding the patient’s discharge to be shared with the ward
and during the year have been involved in ensuring the new Trust website was patient-centric to create greater local awareness. The Patient Panel members continue to write letters of thanks and present novelty cakes to Trust teams following receiving patient compliments.
During the year, the Patient Panel, in partnership with Emma Harnett, Macmillan cancer education lead nurse
32 3333
for Hertfordshire and West Essex Integrated Care Board, and colleagues working across west Essex, organised the One Step at A Time cancer conference that featured videos they had produced on living with cancer. Congratulations also to Emma Harnett, Ann Nutt, Shahid Sardar, associate director of patient engagement and experience at PAHT, and colleagues from One Step at a Time, on winning the Royal College of Nursing Team of the Year award (pictured, from left to right, previous page).
The panel were honoured to meet up with Janice Bernardo, the Trust’s frailty lead, who has worked tirelessly to start the Trust’s Older Persons Assessment and Liaison Unit (OPAL Unit) which supports acute and primary care patient referrals. At the time of their meeting, over 1,300 patients took an active part in research towards a better future for all.
Covid-19 meant the volunteers' Christmas lunch was cancelled, however observing Covid-19 guidelines, the Patient Panel were able to hold a thank you event for their volunteers at Harlow College’s restaurant, attended by Sharon McNally, chief nurse, and Dr Dev Dutta, chair of the Medical Advisory Committee.
The Patient Panel purchased coloured lanyards for PAHT colleagues working in the emergency department (ED) (pictured, above, right).The lanyards aim to help patients and colleagues recognise and identify the different roles within the department easily. They do not usually purchase supplies for departments, however they were keen

to support the team whilst they continue to respond to a high demand for urgent and emergency care services.
Diane Deane-Bowers, vice-chair of the Patient Panel, also took part in the 2022 Healthcare Excellence Through Technology conference (pictured below) and has been asked to present again in 2023.

In March 2023 Ann and Diane were guests at the Medical Advisory Committee's annual dinner, and a good working relationship has been established with the consultant group, from which several new ideas where the Patient Panel can collaborate with the consultants have been established.
Improving care for vulnerable patientsdelirium and dementia
We have made good progress on our goal to deliver the very best possible care for our patients with dementia, in line with national policy. We have in place an integrated dementia strategy, which has key performance indicators in the following areas and is monitored through our Dementia and Delirium Steering Group:
y Find, assess and refer pathway
y Person-centred care (recording of ‘This is Me’)

y Comparison of harm related incidents for patients with dementia (development of a dashboard)
y Training
We have recently participated in round five of the national audit of dementia care in general hospitals, The Royal College of Psychiatrists (2019), round six will commence on 14 August, and the recommendations will inform part of our strategy document.
Admiral Nurse
On 23 March, the dementia clinical nurse specialist (CNS) role (in post, Caroline Ashton-Gough), has converted to that of Admiral Nurse, supported by Dementia UK. Caroline’s role within the Trust is now supported with monthly clinical supervision and access to other training and learning opportunities and will support the strategic development of dementia care at PAHT. Her role will still provide clinical nurse specialist support.

Well-being
In 2019, we undertook a project to introduce singing for the brain into the hospital setting. The aims were to reduce the social isolation that patients often experience during a stay in hospital, to improve wellbeing and mobility. Music therapy is known to play a crucial role in the care of many people with or without dementia, helping to minimise apathy, anxiety, restlessness and depression.
Following the successful pilot, we now provide a weekly music therapy session, which is facilitated by the clinical nurse specialist for dementia and volunteers. The sessions are delivered at the bedside if required on a 1-1 basis or in small groups. The plan for the early part of 2023/24 is to look at expanding the variety of these sessions (a children’s choir are visiting in May).
Feedback from family members and carers has been very positive; there has been a notable change in interaction, improved appetite and reduction in delirium related anxiety.
Delirium
Delirium (sometimes called ‘acute confusional state’) is a common clinical syndrome characterised by disturbed consciousness, cognitive function or perception, which has an acute onset and fluctuating course (NICE 2010). The risk of mortality following a delirium episode in a person with dementia is more than 40%. To support our staff in the care of patients presenting or developing delirium in hospital, we now have established new pathways and guidelines. We also have a leaflet designed to be given to patients and their families or carers. There is a plan to have an electronic assessment.
Training
Dementia training for staff is delivered face-to-face at new colleagues' induciton to the Trust. To support our patients, we have introduced mandatory training on delirium as well as creating dementia and delirium simulation training, which has received excellent evaluation.
This training complements the dementia
34 3535
training that already exists for staff and we are proud of our virtual dementia tour, which enables staff to experience what it may be like to have dementia, and learn how to work with people living with dementia. Additional dementia training has now been introduced into our Preceptorship Programme and Health Care Support worker programme, and is available to all of our people who have regular contact with people with dementia.
Namaste care
Namaste care, 'to honour the spirit within', offers a respectful and supportive approach to care for those living with advanced dementia, integrating compassionate nursing and therapeutic activities. Working closely with St Clare’s Hospice (SCH), we have introduced Namaste care at PAHT with the support of the dementia clinical nurse specialist (Namaste champion),
Pets as Therapy
This project continues to provide such wonderful moments for our patients and our people. The project was developed during 2021/22 and started on 6 April 2022, supported by our voluntary services team. Ward visits with therapy dogs provide reminiscence, conversation, loving touch and comfort (pictured right).

Safeguarding our patients
We have a robust focus and governance process in place to monitor safeguarding concerns. We have a team that oversee provision of advice, guidance and training to staff to ensure we provide care that maintains patients safety. Our specialist safeguarding team work collaboratively with our community partners to ensure this important aspect of patient care is delivered to a high standard.
Sensory garden
We are in the process of identifying and developing a therapeutic, sensory garden space for our patients. We have
who will develop the role of Namaste volunteers in partnership with PAHT volunteers.
A dedicated room space will need to be identified. Currently, Namaste care sessions are delivered twice-weekly and embedding a Namaste approach to delivering compassionate care in every day nursing care. The Dementia CNS works closely with SCH and supports with the Namaste training.
Working with our patients and their carers
We were successful in obtaining funding through NHS Charities to recruit a carers' lead, this is a Band 6 role with a view to extension if successful. We provide a carers' information stand Monday-Friday lunchtimes, this has proved successful and enhanced the communication between carers and ward staff.
Learning from incidents
Patient safety is a priority and we continuously work to ensure that incidents are managed effectively, promptly and most importantly that we learn and share the improvements from them.
A patient safety incident or adverse incident is defined as ‘any unintended or unexpected incident which could have, or did lead to harm for one or more patients receiving NHS funded care’. This includes all terms such as adverse incidents, adverse events and near misses, where an incident was recognised and averted.
For the year 1 April 2022 to 31 March 2023, 13,901 incidents were reported on the Trust’s Datix incident management system; this is a 13% increase from 2021/22.
identified an area for a spiritual garden, a staff area and we are now looking for an area that we can use for our patients and family carers.
Environment
We recognise the environment in hospital can be unsettling for our patients with dementia and delirium. We are working closely with our Patient Panel, our Trust Board and external companies to enhance our environment.
Of the total number of incidents raised in year, 8,118 were classed as patient safety incidents, this is 59%, which is comparable with previous reporting years.

Top 10 patient safety incidents
The top 10 categories of patient safety incidents reported in this financial year are summarised in the graph below. These are reported to the national reporting system to enable learning and comparison with similar sized organisations across the country to occur.

36 3737
Figure 18: Incident reporting data for period 1 April 2022 –31 March 2023
Figure 19: Category of patient safety incidents for 1 April – 31 March 2023
Category of non-patient safety incidents
5783 (41%) incidents reported under the following categories:

y 2,784 monitoring (17%)
y 940 staff related (7%)
y 885 staffing shortage (6%)
y 622 equipment related (4%)
y 461 environmental (3%)
y 389 security (3%)
y 100 visitor related (1%)
There has been an increase in the category of incidents raised classed as monitoring in year, from 11% of the total of non-patient incidents last year up to 17% this year. This is resulting from our teams using the Datix incident reporting system to capture information on:
y number of deprivation of liberty cases (this is where patients are kept in hospital for treatment or continuous supervision, allowed by the Mental Capacity Act)

y safeguarding referrals within and outside of the Trust
y monitoring of operational issues (including 12-hour breaches). This category of incidents are not patient safety incidents.

Serious Incidents
The Trust raised 18 serious incidents (SIs) during the period 1 April 2022 to 31 March 2023.
Once a serious incident investigation is concluded, an action plan is developed to prevent reoccurrence. The Trust uses a sharing the learning report to ensure all relevant staff are:


y aware of the key issues that occurred in this incident
y the changes to practice either implemented or being completed
y what the learning from the incident is to prevent reoccurrence
This is presented and shared widely within the local team where the incident occurred and if relevant to other clinical areas and divisions will be shared across the Trust. This information is reported in Trust-wide reports that are discussed at monthly or quarterly meetings, including the sub-committee of Trust board, the Quality and Safety Committee.
Of the 18 SIs raised in year - three were Never Events. The investigation has concluded for one of these three incidents with a robust action plan being completed.
A subsequent audit to confirm the actions are embedded into staff practice has given assurance this has been completed. The remaining two Never Event SI investigations are ongoing, immediate interim actions were developed until the conclusion of the report is completed.
38 3939 Figure 20:
Category of care incidents were given
Figure 21: Number of serious incidents reported - a two-year comparison of data
Examples of changes implemented as part of learning from incidents
Falls:
Falls improvement work has taken place on the respiratory ward:

y The staff have all completed the falls prevention training
y The team discuss all patients that are at high risk of falling within the ward handovers and safety huddles
y All patients on the ward now have a falls risk assessment within six hours of admission and evidence of this completion is monitored within the regular ward audits
Maternity:
y A new process has been put in place when a woman has an intentional medical device left in place following a procedure. A checklist sticker is placed in the healthcare records. The patient will be given an additional pink wristband as a visual reminder that caution is advised as the woman has a medical device in place
y There has been a change in guidance to ensure a CT urogram is completed for all women who require a caesarean section when they are fully dilated to monitor for a recognised complication of this surgery
Pressure ulcers: Improvement work has taken place with a specific focus on the care of the elderly wards:
y An increase in nurses trained on pressure ulcers on the ward
y Our medicine division wards have a safety huddle template that prompts all ward teams to identify the patients at high risk of both falling and developing pressure related injuries
y The ward manager’s daily audit requires the senior ward nurse to randomly select and review a set of patient nursing healthcare records to complete an assessment of the essential care given
y The pressure ulcer risk assessment tool has been placed on our electronic tool Nervecentre, with the risk score for each patient being reviewed as part of the nursing handover
During this year we have commenced a review of the equality and diversity of patients involved in clinical incidents. This is to determine if there are inequalities in respect to patient safety and particular incident categories having a greater impact for patients from specific groups, genders or ages. This work will continue to evolve over the coming year and we hope will give us useful data that can allow us to focus on any trends identified.
Improving medicine safety

Medicines safety and reducing avoidable harm from medicines is of worldwide significance, with both the launch of the World Health Organisation’s ‘Medication without Harm’ initiative, as well as NHS England’s recently launched Medicines Safety Improvement Programme. Regionally, medicines safety is a core priority as services and pathways begin to become more seamless in the Integrated Care System (ICS).
Despite the increased service demands and challenges around staff resource, medicines safety continues to be a clinical priority, with improvements seen throughout the organisation. Medicines safety will continue to form a key driver of improvement within pharmacy and the wider organisation, as we strive to ensure our patients receive the most appropriate, most effective, and best value treatments, free from avoidable harm.
Medicines agenda and clinical priorities going into 2023/24 Medicines are the most common intervention in medical care. Medicines play a crucial role in maintaining health, preventing illness, managing chronic conditions and curing disease. In an era of significant economic, demographic and technological challenge, it is crucial that patients get the best quality outcomes from medicines.
Medicines optimisation ensures a patient-focused approach to getting the best from and use of medicines, focusing on a holistic approach, an enhanced level of patient-centred professionalism, and partnership between clinical professionals and the patient. In order for medicines optimisation to flourish, it must be patient-centred, based on the most up-to date available evidence, and work collaboratively across the whole ICS. This is the underpinning framework of our medicines strategy.
With the vital role medicines play in

these challenges, and with pharmacy teams already recognised as highly performing and having a successful track record of delivery, the ICS have placed seven key workstreams to deliver these challenges.
1. Optimising our use of digital technology: harnessing the potential of digital technology to offer care in radically different ways and optimise the flow of information and communication across the system.
What this means for PAHT: We will continue to explore how the use of technology can make medicines management safer within the hospital, including upgrading our robotic dispensing, expanding environmental monitoring and introducing automated dispensing cabinets.
2. Clinical leadership: ensuring senior pharmacist representation on all pathways and delivery of patient care
3. Reducing unwarranted variation through use of national benchmarking tools: Utilising business intelligence to benchmark nationally and then identify and improve shortcomings.
4. Ensure appropriate governance and framework to underpin care pathways: Establish the evolving integrated governance model, to facilitate the effective and timely implementation of priority workstreams.
5. Enhance, integrate and optimise use of the pharmacy workforce: Enhance patient care through expanding and utilising staff to their potential, including independent prescribers, consultant pharmacists, and enhanced interface roles.
6. Ensure sustainability is at the forefront of decision making: Reducing the carbon impact medicines have, include reducing inhaler emissions, medicines waste, medical gases and single use plastics
40 4141
Deliver a vision for pharmacy across the ICS footprint: A clear and concise vision to be shared between all sectors of pharmacy, with defined and measurable benefits.
Developing the roles of our pharmacy team
Pharmacists, pharmacy technicians and pharmacy support workers play an integral role in optimisation of pharmaceutical care and delivery at PAHT, maintaining a safe, effective supply chain of medicines. Expanding on their current roles can play a vital role in optimising patient care, reducing wastage, and maintaining patient and medicines safety. With the emergence of the Hertfordshire and West Essex Integrated Care Systems (ICS), the boundaries between primary care, secondary care, community pharmacy and primary care network pharmacists/ pharmacy technicians are slowly being withdrawn, giving rise to potential new roles/care pathways.
The Carter Review (2016) and the subsequent hospital pharmacy transformation programme encourages pharmacists to spend the majority of their time carrying out clinical functions in support of medicines optimisation and the clinical care of patients to reduce the amount of resource devoted to infrastructure services.
Pharmacist and pharmacy technicians have seen their roles expanded considerably, with the introduction of specialist roles (e.g gastroenterology, dermatology, haematology, rheumatology and neurology) as well as the introduction of a specialist pharmacy technician in antimicrobial stewardship. In order to ensure that medicines safety remained at the core of all patient services, the pharmacy workforce strategy was developed.
The pharmacy workforce strategy should meet the demands of the ICS medicines optimisation strategy, the Trust's medicines optimisation strategy, and the PAHT2030 strategy.
Overall, we must ensure the pharmacy workforce are:
y Suitably equipped and trained to perform their role
y Are supported by the right governance structure, policies and procedures and organisational leadership to provide the best everyday care for their patients
y Are inspired and equipped to get the best outcomes for patients
y Are a valued member of the wider MDT, contributing to healthcare agendas within their respective fields
y Staff are proud of their work, with job satisfaction, inspiring future leaders, clear career progression and succession planning embedded throughout practice
y Enhance, integrate and optimise use of the pharmacy workforce
y Collaborate with key stakeholders in the ICS, working towards the development of more interface roles
y Create a shared vision for the medicines strategy, ensuring everyone’s voice is heard
y Promote and champion good practice through both national and local networks, highlighting some of the outstanding work being done
Medicines optimisation outside of ‘normal working hours’
As the complexity of medicines management increases and the relationship between community and hospital care becomes further integrated, the need for core pharmacy services outside of the traditional 9am5pm working hours has become more evident. Medicines reconciliation, medicines review, deprescribing and TTA validation have all demonstrated to be significant barriers to avoidable medicines errors in hospital. The demand for these tasks has led to the development of extended roles on the Adult Assessment Unit (AAU) and Older Person's Assessment and Liaison Unit (OPAL Unit)
From November 2022, our pharmacy have provided a 12 hour, seven day a week service to our Older Person’s
Assessment and Liaison (OPAL Unit).
This is similar to the AAU pharmacy team, which continues to provide a clinical service to the Admissions Unit, 365 days a year. Each pharmacy team consists of experienced pharmacists and technicians who work as part of the MDT to improve prescribing and medication safety from the point of admission and the work done by the team has supported patients on their journey throughout the hospital.
Antimicrobial stewardship (AMS)
The emergence and spread of drugresistant pathogens that have acquired new resistance mechanisms, leading to antimicrobial resistance, continues to threaten our ability to treat common infections. Especially alarming is the rapid global spread of multi- and pan-resistant bacteria (also known as 'superbugs') that cause infections that are not treatable with existing antimicrobial medicines such as antibiotics.
In 2019, the World Health Organization (WHO) identified 32 antibiotics in clinical development that address the WHO list of priority pathogens, of which only six were classified as innovative. Furthermore, a lack of access to quality antimicrobials remains a major issue. Antibiotic shortages are affecting countries of all levels of development and especially in healthcare systems. The UK Government has developed a five-year National Action Plan (NAP), to contain and control these drug resistant bacteria by 2040. As part of this strategy, the use of antimicrobial drugs is heavily scrutinised.
According to the benchmarking results comparing hospitals, it has been identified that The Princess Alexandra Hospital is the worst performing hospital in our region and has one of the highest prescribing rates in comparison with patients' length of days in hospital.
The initials in figure 22 are the abbreviations for all acute hospitals within the East of England region.
To follow on from these results, the Trust has developed an antimicrobial action plan. This involves five key components:
1. Optimising antimicrobial use
y Reduce duration of antibiotic use
y Improve number of patients switched from intravenous to oral antibiotics
within 24 hours
y Reduce antibiotic wastage
2. Organisation development
y Establish AMS engagement across all divisions

y Establish oversight of the Trust teams use of antibiotics, led by the divisional directors
y Create ‘antimicrobial champions’
42 4343
7.
Figure 22: Our antibiotic use over 2022-23, compared with other local Trusts of a similar bed size
3. Support prescribing
y Update our electronic system to ensure antibiotics chosen are in line with Trust and local standards
y Monitor use of antibiotic prescribing on our electronic drug prescription system
4. Develop the AMS workforce
y Empower our multi-profession team members such as physician associates to be the beacons of antimicrobial excellence
y Create a consultant pharmacist role for antimicrobial stewardship
y Creation of a pharmacy technician post
5. Improve training and education
y Mandatory AMS training for all healthcare staff
y Incorporate AMS shared learning into the grand round
Electronic Prescribing and Medicines Administration (EPMA)
y The electronic prescription team continue to work with the clinical teams on improving use of this system. Examples include work with the clinical trials team on Covid-19 protocols, the diabetes team on insulin prescribing, thrombosis group on venous thromboembolism (VTE) assessments, medication given to prevent blood clots and anticoagulant prescribing. This all contributes to safer prescribing and reduction of medication errors
y We continue to develop our reporting through the electronic prescription system with reports to help with ward and team handovers and dashboards. The pharmacy handover report was
recognised by the CQC inspection (2021) as a valuable tool for our pharmacists to target clinical pharmacy interventions
y A big achievement for the last year was the implementation of ChemoCare, a new chemotherapy prescribing system. All oncology and haematology protocols are now prescribed, validated, prepared and administered using the new system. This has greatly improved the safety of the chemotherapy processes in the Trust
Medication incidents
Medication incidents are reported via the Datix incident reporting system. There are two metrics that are nationally reported to measure of medicines safety and governance.
y Medication Incidents Rate per 1,000 bed days

y Percentage Medication Incidents


Reported as Causing Harm or Death/ All Medication Errors
A Trust that is frequently reporting medication incidents, with a low percentage of incidents causing harm, is recognised as having a good organisational ethos with regards to patient safety. These are also reported as part of a hospital pharmacy’s benchmarking process, known as ‘model hospital’. Reporting of medication incidents continues to be high, but the percentage of incidents that have resulted in patient harm is also above average for the UK.

Trust wide sharing the learning from medicine incidents occurs across three focused pathways:
y Pharmacy: Learning from incidents are shared at weekly Wednesday pharmacy meetings
y Nursing: Learning is shared at monthly meetings chaired by the Medicines Safety Officer, at daily huddles and at senior practitioner forums
y Medical: Learning is shared with doctors at grand round, and at mortality and morbidity meetings
A total of 874 incidents related to medicine have been reported via the Datix system in the last 12 months, of which 770 (88.1%) resulted in no harm, 91 (10.4%) in minor harm, 11 (1.2%) in moderate harm, and 2 (0.2%) in severe harm.
44 4545
Figure 23: Number of reported medication incidents/per 1000 bed days
Figure 24: % of medication errors that cause harm
Figure 25: Medication incidents by harm over 12 months
Figure 26: Incidents over 12 months by level of harm
Patient group directions
Patient group directions are written directions to administer medication without the need for a prescription. They improve medicines uptake and access without compromising patient harm. Patient group directions require specialist input, good quality governance and monitoring, and the systems have been refined over the last 12 months including:
y The introduction of a PGD review group to evaluate new and existing PGDs before ratification by the Medicines Optimisation Group
y A training programme that is uniform and consistent throughout the organisation

y An audit programme to review PGDs

y An electronic process for signing and tracking the progress of PGDs that have been reviewed and ratified

Technical services
The ability to aseptically prepare chemotherapy for our patients is vital for any organisations that treat cancer. The current outdated unit carried a high risk of microbe contamination and treatment delays. This year, a business case was accepted for a new modern facility to manufacture treatments to the highest standard, and as construction and quality assurance nears completion, the unit will begin manufacturing in June 2023.
Our people
Table 2: People KPI 2022-23 target Year to date performance
Time to hire 42 days 44 days
Recognising our amazing people
In our annual This is Us - Our Amazing People Awards 2022, over 400 of our PAHT people, including our volunteers, were nominated for an award. Of these nominations, 115 individuals and 15 teams were shortlisted across 12 This is Us awards categories based around each of our values: patient at heart, everyday excellence, and creative collaboration.
Shortlisted colleagues were invited to one of three values-themed awards evenings at the end of June, where certificates, badges and awards were presented to our 24 winners by the executive and non-executive directors. These events were a fantastic opportunity to recognise our people, who go the extra mile in their work to best support our patients and colleagues.
The awards events were held as part our annual engagement event – This is Us Week - and were also live-streamed to enable colleagues across the organisation to attend to show support and appreciation.
Our Long Service Awards also took place during This is Us Week. This evening of celebration gave people the opportunity to be recognised by their colleagues and our executive and non-executive directors. More than 50 colleagues with over 20 and 25 years of PAHT service were invited to join the 2022 event, with many being able to attend. Long-serving colleagues received certificates, badges and glass awards. This event was also live streamed, with colleagues joining to celebrate.

46 4747
Vacancy rate 8% 9.9% Sickness absence 4.3% 4.4% Voluntary turnover 12% 16.3% Statutory and mandatory training 92% 89% Appraisal 90% 84.2%
Celebrating our amazing PAHT people


A huge congratulations to our people who were nominated and highly commended at our This is Us awards ceremonies. Please take a look at some of the photos of our amazing #PAHTPeople - well done to all.









































48 4949
Other accolades for our #PAHTPeople included...
Dedicated nurse Caroline Ashton-Gough (pictured left) was awarded a prestigious High Sheriff’s Award in recognition of the valuable contribution she has made to PAHT and patients living with dementia.

The High Sheriff's Awards are designed to reward the volunteers, charities, organisations and community groups in Essex who devote their time and energy to improve the communities in which they live and work.
A team who are committed to enhancing cancer care services won a national award. The One Step at a Time team (pictured left), which includes colleagues from PAHT, The Patient Panel at PAHT, and the Hertfordshire and West Essex Integrated Care Board, won the Team of the Year category at The Royal College of Nursing (RCN) Awards 2022 in recognition of their work to promote the patient voice.
The compassionate care Namaste voluntary services team were shortlisted for a prestigious award.


The team (pictured left) reached the finals of the Helpforce Champions Awards 2022 and were highly commended in the Outstanding Team of the Year category.
The recruitment team, in collaboration with IT colleagues, won the Health Tech Digital Digital Transformation Project of the Year Award for the staff onboarding project.

The National NHS Staff Survey

The annual NHS National Staff Survey (NSS) is recognised as an important tool for ensuring that the views of people working in the NHS are used to help inform local improvements. The feedback is useful in helping highlight strengths, and improvements that will make PAHT a better place to both work and be treated.
A full census was held at PAHT between October and November 2022, with all our people having the opportunity to take part. In total, 1,881 (49.5%) completed their survey, which was 2.3% higher than 2021, and 5% higher than the median acute Trust response rate (there are 124 acute Trusts within the benchmark group).
The maternity team received the prestigious gold award as part of UNICEF’s Baby Friendly Initiative.

The initiative is based on a set of evidence-based standards which are designed to support families with feeding and developing close, loving relationships, to support with optimum health and development.
The report findings from the 2022 National Staff Survey were presented to the People Committee and the Senior Management Team in March 2023. The results were communicated to the wider organisation through an all user email from Lance McCarthy on the day of the national results release (9 March 2022), accompanied by an InTouch briefing (online webinar). The update was then shared widely across our other internal communications channels. Written responses to the results at a divisional level were also sent to colleagues by divisional senior management teams.
A Feedback to Action programme of support has been developed for each division to implement to fully review the findings and commence the development of Staff Survey improvement plans. These plans align to four priority improvement actions identified by the Trust (continuing from
those identified for 2021-22):
y Priority one: improving the physical and mental health and wellbeing of our people
y Priority two: improving our learning and safety culture, encouraging people to openly share feedback or concerns and ensure this is acted upon - improving psychological safety
y Priority three: embedding our This is Us management practices and leadership promise in our ways of working
y Priority four: ensuring our workforce plans support teams being effectively staffed to deliver high quality services
These continue to be key areas of importance as we continue to strive to deliver care in line with our values and our quality and patient safety strategy. Representatives from every team in the organisation will be encouraged to
50 5151
Figure 27: Summary of the Trust’s results by the key national themes, benchmarked against both acute and community organisations
join a Feedback to Action group within their division, to share their views on the results and inform improvement actions.

We recognise that developing impactful improvement plans is dependent on involving a wide range of our people in identifying meaningful positive changes – and are confident that the Feedback to Action approach can support us to do this.
How was improvement action taken during 2022/23?
y Workshops were held from March to May 2022 with leads from all divisions, to review the results and identify improvement suggestions. Improvement plans were developed (April 2022) targeting improvement actions linked to the Trust’s four key Staff Survey improvement priorities
y Staff Survey results roadshows were held between May to June 2022 to share these plans with wider staff and seek further feedback and suggestions
y Improvement actions were implemented at a local level, including for example:
y Introduction of regular team meetings and 1:1 meetings within estates and facilities
y Increased visibility and awareness of safety champions within child health and women’s services
y Introduction of weekly senior management visits to clinical teams in the medicine division
y Reintroduction of leadership team walk-arounds fortnightly within the surgery division
y Running psychological support sessions within the urgent and emergency care division
y Introduction of culture huddles within the clinical support services division
y A range of actions across corporate services focused around enhancing development and involvement opportunities
y A wider range of health and wellbeing support resources were made available to all staff, including the introduction of cost-of-living support measures
y Introduction of This is Us Week, offering a six-day engagement programme hosting annual awards, a summer celebration barbeque, learning and networking events, and so much more
y Introduction of This is me as our new approach to learning, development and performance, including refreshed learning offers for all our people, including a dedicated managers’ development programme, and the development a new interactive appraisal conversations tool
y The PAHT 2030 Ready programme was completed with our senior managers, equipping them with the skills and knowledge to engage their teams in taking forward our PAHT 2030 strategy
Equality, diversity and inclusion
Our aim is for everyone to feel valued, included, with a sense of belonging and proud to be part of PAHT. Outlined below are a number of programmes and initiatives in place to promote inclusion for our people.
y The Race, Equality and Cultural Heritage (REACH) staff network has become an integral part of our colleagues' support for one another, as well as feeding into equality work across the Trust. The focus is on encouraging a culture of fairness, not only for Black, Asian and minority Ethnic (BAME) colleagues, but all of our people. As part of this continued support, the network chair and seven members have been provided with bespoke coaching and development by external provider Krystal Alliance to enhance leadership skills and the effectiveness of the network
y The Disability and Wellbeing Network (DAWN) was established in February 2022. A short film on registering as disabled with personalised messages
from Hattie Llewelyn-Davies, chair, and Anne Wafula-Strike, associate nonexecutive director, was produced and shared with all of our people
y We launched the NHS Rainbow Badge initiative with support of the LGBT+ Staff Network. Staff are being encouraged to sign up to wear a rainbow NHS badge as a visible demonstration that our Trust is an open, non-judgemental and inclusive place for people who identify as LGBT+
y We commenced work with EmployAbility, a specialist employment charity supporting people with mental ill health to secure and retain employment. We delivered interview skills sessions to members of Employ-ability.
y We have become the first NHS hospital in Essex to sign up to a new antiracism charter. On 23 March 2022, in recognition of International Day for the Elimination of Racial Discrimination, we signed the anti-racism charter, developed by trade union UNISON, at a special ceremony that commits us to a range of pledges designed to prevent racial bias
y Work continues with the Integrated Care System (ICS) on the countywide inclusive career development programme. PAHT is supporting with the facilitation of the programme to ensure that we are suitably represented on the initiative. Four PAHT staff at band Agenda for Change (AfC) bands 2 and 5 have completed the programme
y We deliver a face-to-face equality, diversity and inclusion session on
day one of the corporate induction to ensure that all new starters are aware of our approach to equality, diversity and inclusion and understand the expectation that everyone is treated with respect
y We have rolled out inclusive recruitment training to equip managers with the skills and knowledge to attract the best candidates in a fair and objective way. An engaging approach underpins the training, with a focus on behaviour change
y As part of This Us Week, an EqualiTEA afternoon tea was offered to our people to celebrate the diversity and inclusivity of our teams at PAHT
y We have rolled out equality, diversity and inclusion (EDI) champions on all interview panels at band 8a and above
y The equality, diversity and inclusion steering group, chaired by the deputy director of people, consists of senior colleagues, operational leads, staff equality networks and interested parties, ensuring that equality, diversity and inclusion is championed across the Trust. The group meets every six weeks. The purpose of the steering group is to ensure compliance with equality legislation, to promote awareness of EDI issues and to support the integration of diversity initiatives into the workforce. The steering group regularly reports progress to the Workforce Committee, as a sub-committee of the Board, to ensure visibility and scrutiny of all interventions. There is regular reporting on EDI to People Board and JSCC.
52 5353
Our performance Operational performance
The Trust’s operational performance against national and local standards is monitored and reviewed at:
y Regular Performance Review Meetings between members of the executive team and each division or department
y The Urgent Care Board
y The System Access Board
y The Cancer Board
y Senior Management Team meetings
y The Performance and Finance Committee
y Trust Board meetings
An Integrated Performance Report is presented to the Performance and Finance Committee, Quality and Safety
Committee and Trust Board meetings. Externally, the Trust is held to account for its operational performance by NHS England/Improvement and its commissioners.
Targets and national standards

Delivery of all national standards has continued to be significantly impacted by the increased elective waiting lists caused by Covid-19 and further increased numbers of emergency patients requiring care. During the year the hospital has returned to a sustainable level of facilities that enable treatment of elective and emergency patients with separate care of patients with infections such as Covid-19 and Influenza, figure 28. This has enabled more capacity for elective care during 2022/23 than in the past two years.
The 18 week Referral to treatment (RTT) standard was impacted by the long waiting times for treatment for patients, with approximately 50% of our patients waiting over 18 weeks for routine treatment. Urgent and cancer treatments continue to be delivered in under 18 weeks. The Trust continues to book patients in clinical priority order and has been successful in ensuring the highest priority patients are being booked within a month of making a decision to treat (P2s).

The Trust has also reduced the number of long waiting patients with patients over 78 weeks steadily reducing over the year and ensured that there were no patients waiting over two years for treatment in summer 2022. The Trust aimed to treat all patients waiting longer than 78 weeks by 31 March in line with the national requirement, but finished the year with 14 patients to be treated after this date as a result of cancellations due to industrial action in March.
Delivery of the national cancer standards has continued to be impacted by the number of patients waiting over 62 days for their treatment due to Covid-19, however significant progress has been made in reducing the long waits. The Trust achieved the national requirement to reduce the backlog of patients back to pre-Covid levels (February 2020) at 31 March 2023 and aims to exceed the March 2024 standard set in 23/24. A current cancer recovery plan has been implemented across all specialties and two large improvement projects in colorectal and urology are planned for early 2023/24, figure 30 and 31 below.

The Trust is committed to the delivery of all national cancer standards and good progress is being made in early 2023 with the faster diagnosis standard and the two week wait first appointment measures.
Full elective operating was delivered during winter 22/23, although the elective orthopaedic ward was closed for two weeks in January to support the increased emergency admissions. Critical care capacity has been challenged during 22/23 with a number of elective critical care cases requiring re-scheduling due to emergency pressures, figure 29 referral to treatment access target.
Figure 29: Referral to treatment 52 week waits

54 5555
Figure 28: Referral to treatment incomplete
Figure 30: 28 day faster diagnosis performance by month
Diagnostic performance

Diagnostic performance has also been impacted by backlogs of routine patients waiting longer than six weeks for their diagnostic. Cancer and urgent diagnostics continued and levels the diagnostics department delivered additional activity to both the emergency department, cancer pathways and to reduce the backlog.




Diagnostic services are performing above their recovery trajectory and the Trust is delighted to report that CT reported above the new 95% against the
national standard from December 2022, see figure 33 below. The Trust aims to achieve the overall national standard by August 2023, with the exception of audiology which has a separate improvement plan. The opening of the third CT machine and the replacement of the MRI equipment at St Margaret’s Hospital ensured resilience in diagnostic capacity in the year.
56 5757
Figure 31: Cancer 28 day faster diagnosis
Figure 32: 62 day PTL backlog by month
Figure 33: Diagnostics
6 week waits
Figure 34: Patients with a length of stay more than 7 days
Participation in clinical audits
We are committed to undertaking effective clinical audit across all clinical services and recognise this is a key element for developing and maintaining high quality, patient-centred services.
During 2023/23, the Trust participated in 88% of the eligible national clinical audits. Of the six national confidential enquiries, the Trust has participated
Table 3
Programme / work stream (AZ)
Breast and Cosmetic Implant Registry

Case Mix ProgrammeICNAR-C
Child Health Clinical Outcome
Review Programme –Transition from child to adult health services
Child Health Clinical Outcome
Review Programme –Testicular torsion
Chronic Kidney Disease registry
in five, 83% of the studies which it is eligible to participate in. The national clinical audits and national confidential enquiries that the Trust participated in and for which data collection was completed during the 2022/23 period are listed below alongside the current stage/ reasons for not taking part to each audit or enquiry where known.
Provider organisation Participation Stage/submission details
Table 3
Programme / work stream (AZ)
Cleft Registry and Audit Network Database
Provider organisation Participation Stage/ submission details
Royal College of SurgeonsClinical Effectiveness Unit
Not applicable
Elective Surgery (National PROMs)
NHS Digital Yes
Continuous data submission
NHS Digital Yes 100%
Intensive Care National Audit & Research Centre
National Confidential Enquiry into Patient Outcome and Death
Yes Continuous data collection
Emergency Medicine Quality Improvement
a. Pain in Children (care in emergency departments)
b. Care of older people
Royal College of Emergency Medicine
a. Yes
a. October 21 to October 22 = 44 - data submission continues
b. Yes
National Confidential Enquiry into Patient Outcome and Death
The Renal Association/The UK Renal Registry
Yes Organisational questionnaire submitted April 2022 and clinical questionnaires cancelled as did not meet the criteria
Yes Data collection period still open
c. Mental health self harm
c. Yes
b. Data submission period still open
c. Data submission period still open
Not applicable only for renal centres
Falls and Fragility Fracture Audit Programme
a. Fracture Liaison
b. National Audit of Inpatient Falls
c. National Hip Fracture Database
Inflammatory Bowel Disease Audit
Learning from lives and deaths – People with a learning disability and autistic people (LeDeR)
Royal College of Physicians
b. Yes
c. Yes
100% Continuous data collection
IBD Registry Yes Continuous data collection
NHS England Yes 100%
58 5959
Table 3
Programme / work stream (A-Z)
Maternal and Newborn Infant Clinical Outcome Review Programme
a. Perinatal mortality surveillance
b. Maternal mortality surveillance
Medical and Surgical Clinical Outcome Review Programme
a. Crohns disease
b. Endometriosis
c. Epilepsy study
Provider organisation Participation Stage/submission details
University of Oxford /MBRRACE-UK collaborative
Yes Yes
100% 100%
Table 3
Programme / work stream (A-Z)
National Asthma and Chronic Obstructive Pulmonary Disease Audit Programme 1, 2, 3:
a. Paediatric Asthma Secondary Care
b. Adult Asthma
Secondary Care
Provider organisation Participation Stage/submission details
Royal College of Physicians
Mental Health Clinical Outcome Review Programme
National Adult Diabetes Audit
a. National Diabetes
b. National Pregnancy in Diabetes Audit
c. National Diabetes Footcare Audit
d. National Inpatient Diabetes Audit, including National Diabetes In-patient Audit – Harms
National Confidential Enquiry into Patient Outcome and Death
Yes Yes Yes
a) Clinical questionnaire submitted –organisational questionnaire partial submission
b) Data submission period still open
c) 33%
c. Chronic Obstructive Pulmonary Disease
Secondary Care
d. Pulmonary RehabilitationOrganisational and Clinical Audit
National Audit of Breast Cancer inOlder Patients 1, 2
National Audit of Cardiac Rehabilitation
a. Yes
Less than 5 cases
b. No
c. No
d. Not applicable
Royal College of Surgeons Yes Continuous data collection
University of York Not applicable
University of Manchester/NCISH
Not applicable
NHS Digital
a. No
b. Yes c. Yes d. Yes
Insufficient software 100% Data submission period still open
National Audit of Cardiovascular Disease
National Bariatric Surgery Registry
National Audit of Care at the End of Life
NHS Benchmarking Network Not applicable
British Obesity & Metabolic Surgery
Not applicable
NHS Benchmarking Network Yes 39 cases (out of 40) equal to 97.5%)
National Audit of Dementia Royal College of Psychiatrists Yes
National Audit of Pulmonary Hypertension
National Audit of Seizures and Epilepsies in Children and Young People (Epilepsy 12)
National Cardiac Arrest Audit
NHS Digital Not applicable
Royal College of Paediatrics and Child Health
Intensive Care National Audit and Research Centre /Resuscitation Council UK
Yes Continuous data collection
Yes Continuous data collection
60 6161
100%
National Cardiac Audit Programme
a. National Audit of Cardiac Rhythm Management
b. Myocardial Ischaemia National Audit Project
c. National Adult Cardiac Surgery Audit
d. National Audit of Percutaneous Coronary Interventions (PCI) (Coronary Angioplasty)
e. National Heart Failure Audit
Barts Health NHS Trust a. Yes
b. Yes c. Not applicable
3 Programme /
work
Gastrointestinal Cancer
National Clinical Audit of Psychosis Royal College of Psychiatrists Not applicable
National Emergency Laparotomy Audit Royal College of Anaesthetists Yes Data submission period still open National Lung Cancer Audit Royal College of Physicians Yes Continuous data collection Table
1

62 6363
Provider organisation Participation Stage/submission details
Table 3 Programme / work stream (A-Z)
d.
Continuous
Continuous
f. National Congenital Heart Disease collection Continuous
Not applicable e. Yes f. Not applicable
data collection
data
data collection
National Child Mortality Database University of Bristol Not applicable Data comes from Child Death Overview Panels
National Early Inflammatory Arthritis stream (A-Z)
British Society of Rheumatology Yes Insufficient capacity to submit cases at present Provider organisation Participation Number/ % submitted National
a. National Oesophago-gastric Cancer
National Bowel
Audit NHS Digital Yes Yes Continuous data submission (submitted annually
–
year
Continuous data submission (submitted
– 1 year
National Joint
Healthcare Quality Improvement Partnership Yes Continuous data collection National Maternity and Perinatal Audit Royal College of Obstetrics and Gynaecology Yes Continuous data collection National Neonatal Audit Programme Royal College of Paediatrics and Child Health Yes Continuous data collection National Paediatric Diabetes Audit Royal College of Paediatrics and Child Health Yes 100% National Perinatal Mortality Review Tool University of Oxford / MBRRACE-UK collaborative Yes 100%
b.
Cancer
and retrospectively
behind)
annually and retrospectively
behind
Registry
Neurosurgical
Out-of-Hospital Cardiac Arrest Outcomes
Paediatric Intensive Care Audit

Prescribing Observatory for Mental Health
a. improving the quality of valproate prescribing in adult mental health services
b. The use of melatonin
Respiratory Audits
a. Adult Respiratory Support Audit

b. Smoking Cessation Audit - Maternity and Mental Health Services

University of Warwick
University of Leeds /University of Leicester
Royal College of Psychiatrists
Not applicable
Not applicable
Not applicable
British Thoracic Society
a) Yes
b) Not applicable for this period
a) Opened 01.02.23 data period until 31.03.23 submission open until 12.06.23
b) Not planned to start
64 6565
Participation Number/ % submitted National Prostate Cancer Audit Royal College of Surgeons Yes Continuous data collection National Vascular
Royal College of Surgeons Yes Submission deadline recently passed awaiting confirmation of submission %
Table 3 Programme / work stream (A-Z) Provider organisation
Registry
National Audit Programme
The Society of British Neurological Surgeons Not applicable
organisation Participation Number/
submitted Sentinel Stroke National Audit Programme King's College London Not applicable Serious Hazards of Transfusion Serious Hazards of Transfusion Yes 100% Society for Acute Medicine Benchmarking Society for Acute Medicine Yes Continuous data collection Trauma Audit & Research Network The Trauma Audit & Research Network Yes Continuous data collection UK Cystic Fibrosis Registry Cystic Fibrosis Trust Not applicable UK Parkinson's Audit Parkinson's UK Yes 100%
Table 3 Programme / work stream (A-Z)
Provider
%
Research and development

Figure 35 above shows that there were 14 commercial portfolio studies open throughout 2022-23, 7 are still open to recruitment, 5 are closed to recruitment but in follow up and 2 were open during the year but have since been closed.

We had 73 non-commercial studies open in total for 2022-23. 49 of these are still currently open to recruitment, 20 are closed to recruitment but in follow up and 4 were open during the year but have since closed.

66 6767
Figure 35: Active studies
Recruitment Speciality Division Type Portfolio activity 9 Critical care Surgery Non-commercial 108 Cancer CSS Non-commercial 1 Infection CSS Non-commercial 73 Gastro Surgery Non-commercial 55 Ophthalmology Surgery Non-commercial 8 Respiratory Medicine Non-commercial 3 Respiratory Medicine Non-commercial 94 Emergency Urgent and emergency care Non-commercial 8 Emergency Urgent and emergency care Commercial 67 Rheumatology Surgery Non-commercial 1 Rheumatology Surgery Commercial 168 Obstetrics/ maternity Family and women's services Non-commercial 13 Trauma and orthopaedics Surgery Non-commercial 7 General surgery Surgery Non-commercial 32 Diabetes Medicine Non-commercial 26 Anaesthetics Surgery Non-commercial 109 People Corporate Non-commercial Table
per speciality
Figure 36: 2022/23PAHT accrual figures
4: Research recruitment
Our places
Improving our estate
To be a modern, integrated and outstanding hospital, our estate requires significant ongoing investment to enable us to provide the best services possible. During the last year, the Trust invested in the estate, transforming a number of key sites that have since brought significant improvements to our operations.
This is not just about investing in spaces and places, it is about investing in our people and our patients; listening to their needs, understanding what we can do better to provide and maintain the very best environment to deliver and receive care.
We have a responsibility to invest to improve the health of the planet too, and during the last year have introduced a number of initiatives to reduce our environmental impact in line with wider NHS green targets.
In 2022-23, the PAHT estate was remodelled and maintained to improve the experience for everyone in the hospital by:
y Improving the management of buildings and engineering systems
y Providing excellent and sustainable facilities
y Ensuring safety and security at all times
The capital programme for this year was circa £8m, this included a £3.8m investment in backlog maintenance and continued investment in our patients and people.
Our patients have benefited from the following completed schemes:
y New Aseptic Suite (TSU) – now relocated into Arendal House to serve the adjacent Williams Day Unit chemotherapy unit
y Creation of a new HV/LV transformer building to Northside with new UKPN supply to provide site resilience and Trust owned connecting switch panel
y Mental health room upgrades in the main emergency department (ED),
In addition to these projects, the following projects were completed in 2022-23:
Adult Assessment Unit (AAU)
and paediatric ED
y Upgrade of the main kitchen to meet EHO requirements for serving
y Refurbishment of highlighted public toilets
y Tye Green Ward physiotherapy conservatory reroofing project
y Installation of new heating and cooling systems in various wards
y Relocation of therapies/hot clinics and paediatric departments to Gibberd Ward for improved flow over winter
y New medical gas pipework installation into main theatres along with new AVUS’s to provide safer and better control and monitoring
y Discharge lounge/Clinical Decisions Unit in ED for better patient flow
y Installation of new external and internal wayfinding across site for better patient experience accessing the site
y Installation of new AGSS system and ventilation systems to the maternity department for gas and air safe use.
Our amazing people have benefited from the following completed schemes designed to support their welfare and wellbeing:
y Upgrade works to Macmillan bungalow offices
y Upgrade works to patient experience team (PET) offices
y Upgrade works to consultants' offices
y New heating and cooling systems across site
y Upgrade of old safeguarding modular unit for agile working
y Upgrade of main kitchen for a more compliant working environment
y Installation of new AGSS system and ventilation systems to maternity department for gas and air safe use
y New turnkey state of the art CT scanner in the radiology department
y Replacement of obsolete electrical switchgears across the organisation
y Wireless nurse call system replacement and removal of old
y Fire compartmentation works across site with upgrades.
y Boiler House upgrade works and support areas
y New boiler set to serve campus houses and clinical areas
y Renewal of RO water units to Gibberd Ward/outpatients' department (OPD) and boiler house
y Replacement of failed flooring to prevent slips, trips and falls
y Various roofing projects where leaks were evident
y Replacement of failed heating parts on infrastructure within the basement
y Emergency water main and pipework repairs
y Various replacement/new heating and cooling systems to clinical and administration areas across the site
Annual Sustainability Report 2022-23
Background
In 2020, the NHS Shared Business Services Authority declared a climate emergency, noting that the health and care system in England contributes 4-5% of the country’s carbon footprint. It also recognised global climate change as the greatest threat to human life in the 21st century.
Reducing its carbon emissions will take pressure off the healthcare system and ultimately save lives. Therefore, the NHS is committed to reaching net-zero carbon emissions by 2045 against 1990 emission levels through:
1. Reaching net zero by 2040 for the emissions we control directly (the NHS Carbon Footprint), with an 80% reduction by 2028 – 2032.
2. Reaching net zero by 2045 for the emissions we can influence but don’t directly control (the NHS Carbon Footprint Plus), with an 80% reduction by 2036 –2039.
In line with the above and to comply with the Standard NHS Contract requirement along with other NHS Trusts, PAHT submitted the Board approved three-year Green Plan to the Integrated Care Board (ICB) on 14 January 2022. Following this, the ICB issued a collated green plan. Each Trust is required to deliver its green plan. PAHT is working collaboratively with the ICB and regional greener NHS teams to deliver the objectives of our green plan and the priority areas.
Being greener at PAHT
Travel and transport
The ‘Greener’ NHS statutory requirement for travel and transport requires each Trust to contribute towards:
Ensuring that the region’s owned and leased fleet is made up of at least 90% Low Emission Vehicles (LEV) by March 2024. This should include a target of 5% of the fleet being made up of Ultra-Low Emissions (ULEV) and Zero Emission Vehicles (ZEV) by March 2023, ensuring that all vehicles (under 3.5 tonne) purchased or leased from 1 April 2022 onwards are ULEVs or ZEVs
To fulfil this travel and transport requirement, the Trust carried out an electric vehicle trial in partnership with four vehicle manufacturers (Toyota, MG, Renault and LEVC) from April 2022 –June 2022. The trial involved the patient at home team and facilities delivery drivers who drive our current fleet vehicles on a day to day basis. The trial was a complete success, with our people happy and promoting the use of these vehicles going forward.
Following the success of our electric vehicle (EV) trial, the Trust has approved funds for installation of dedicated electric chargers and the lease of six electric vehicles for the estates and facilities department. The swapping of the existing fossil fuelled fleet to electric vehicles will make PAHT one of the leading Trusts to implement this change within our Integrated Care System (ICS). Benefits will include reduction in our transport related carbon emission, cost savings,
68 6969
corporate image enhancement and employee satisfaction (morale boost) because the drivers selected the vehicles themselves.
Energy Contract:
We have successfully hedged our utilities (gas and electricity) contracts until 31 September 2023, with a further flexible procurement contract approved by the Board to help the Trust avoid any cost pressure from the current volatile energy market and actualise any potential financial benefits despite the current high energy prices and the geopolitical influences on international energy market.
Renewable energy supply
The electricity contract supplies 100% renewable energy at no premium cost and it is Renewable Energy Guarantees Origin (REGO) certified. This satisfies a key focus area of the greener NHS net zero requirement

On-site energy generation
PAHT has generated 641,896 kWh of electricity power (enough to watch television for over 6.4million hours) from the Solar Photovoltaic (Solar PV) system installed on site. This leads to a total of 325,894kg of carbon dioxide saved by not using electricity from the national power grid supply which burns fossil fuels and releases CO2 into the atmosphere. It also generated a total revenue of £19,156 from March 2021 to November 2022.
Recycled paper
In conjunction with the procurement team, we have a system in place to support the purchase of 100% recycled paper for the Trust’s paper printing. This gives marginal cost savings but the reduction in carbon emissions and environmental impact is significant.
Data collections
We have successfully participated in data collection submissions for decarbonisation schemes and working with the ICS to submit quarterly data
returns
to
the
NHS England/Improvement (NHSE/I) for gathering of information for sustainability reporting.
Staff engagement
To embed the Trust’s sustainability agenda and create awareness, we have undertaken sustainability update meetings with staff groups and departments in the Trust, including the medical advisory committee, surgeons and the facilities team.

Waste Clinical waste

The Trust is partnering with a behavioural change specialist company to support our clinical waste management and HTM07-01 compliance. The team carried out over 11,000 waste bin audits in 2022-23 and have delivered more than 750 one-to-one training sessions with front-line staff. This results in a reduction of 31 tonnes (650 in 2021-22 to 618 in 2022-23) in the volume of clinical waste disposed of and a split ratio of 47:43:11 for our offensive, infectious and incineration waste streams. This has brought us closer to the desired 60:20:20 split recommended by NHS Improvement as well as giving direct cost savings of £7,467 and a significant cost avoidance despite the increase in price per tonne from the service providers.
General waste and waste recycling
There was an increase in volume of domestic waste generated this financial year compared to the previous year. 97% of all domestic waste was diverted from landfill and either recycled or incinerated for Energy from Waste (EfW). 156.25 tonnes (19.1%) of the total domestic waste was recycled – figure 2 (overleaf).

Waste volumes (tonnes): Total waste
818 tonnes, general waste 662 tonnes, recycled waste 156 tonnes.
Clothing bank
The Trust charity has a clothing bank in the hospital for the recycling of clothing items to help reduce carbon footprint and support our local community. The reuse and recycling scheme will lessen impacts on overflowing landfill sites by extending the useful life of clothing items and minimising waste. The scheme supports the prevention of homelessness and provision of pop-up accommodation for rough sleepers. In five months, 1.16 tonnes of clothing items have been collected.
70 7171
(%):
Figure 37: Waste types and volumes
Response to The Princess Alexandra Hospital NHS Trust
Quality Account 2022-2023
Introduction
Healthwatch Essex is an independent organisation that works to provide a voice for the people of Essex in helping to shape and improve local health and social care. We believe that health and social care organisations should use people’s lived experience to improve services. Understanding what it is like for the patient, the service user and the carer to access services should be at the heart of transforming the NHS and social care as it meets the challenges ahead.
We recognise that Quality Accounts are an important way for local NHS services to report on their performance by measuring patient safety, the effectiveness of treatments that patients receive and patients’ experiences of care. They present a useful opportunity for Healthwatch to provide a critical, but constructive, perspective on the quality of services, and we will comment where we believe we have evidence – grounded in people’s voice and lived experience – that is relevant to the quality of services delivered by The Princess Alexandra Hospital NHS Hospital Trust (PAHT). In this case, we have received no additional feedback about services provided by PAHT, and so offer the following comments on the PAHT Quality Account 2022-2023.
What is encouraging to see?
y It is reassuring to see that PAHT recognises the importance of staff feedback; encouraging staff to share their positive and critical perspectives without fear of reprisal through the Freedom to Speak vision and strategy and Freedom to Speak Up Guardians
y At Healthwatch Essex, we are committed to ensuring that the voices of Essex residents are embedded in service improvements across the county. We therefore support the work of PAHT’s Patient Panel and are pleased to see that its positive impact has been recognised by the CQC and the Queen’s Award. We support PAHT’s efforts to make Patient Panel meetings accessible by using approaches like Microsoft Teams to ensure that members can attend
y We are also pleased to see that PAHT are committed to obtaining patient feedback in different ways. Disseminating the patient friends and family feedback test via text message, for example, has led to an increase in responses
y As advocates for patient voice, it is promising to see that patients are being actively involved in decision-making about their medication. PAHT have also promoted patient agency via their patient managed pathway pilot for longterm conditions (with an initial focus on inflammatory bowel disease). We are interested to see how this pathway develops and what learnings PAHT will obtain
y It is encouraging that there were no cases of validated deaths due to quality of care over the period
y Healthwatch Essex are also pleased to hear that PAHT are now in a far better place contending with Covid-19, with a general fall in COVID-19 hospital admissions and a notable reduction in the number of patients developing severe illness as a result of the Omicron variant
y Healthwatch Essex supports PAHT’s efforts to be more inclusive, as demonstrated by the launch of the NHS Rainbow Badge initiative and their commitment to the Anti-Racism Charter
Is there anything that is disappointing to see?
y As highlighted by the Care Quality Commission (CQC), it is disappointing that many aspects of PAHT’s maternity, medicine, and urgent and emergency care services were deemed to require improvement. Aspects of emergency care services were singled out as ‘inadequate’. Healthwatch Essex recognise the steps that PAHT are taking to improve their services in response to this inspection outcome
y Only 42.5% of staff reported that they would be happy with the standard of care provided by PAHT if a friend/relative needed treatment
y It is disappointing that the 18-week Referral to Treatment (RTT) standard was impacted by the long waiting times for treatment for patients, with half the Trust’s patients waiting over 18 weeks for routine treatment. As referenced in the Quality Account, diagnostic performance has also been impacted by backlogs of routine patients waiting longer than 6 weeks for their diagnosis
y Healthwatch Essex acknowledges the importance of patient data in ensuring the success of service improvement measures. It is therefore disappointing that an absence of skilled coders in the clinical coding team meant that data was not collected for the Hospital Standardised Mortality Rate (HSMR) from May-August 2022. We recognise the steps that PAHT are now taking to recruit coders and train staff
y It is also a disappointment to see a 13% increase in patient safety incidents from 2021-22, with a large proportion of these being in-patient falls
Are there things that could be improved?
y Whilst Healthwatch Essex recognise the Trust’s efforts to improve the health and wellbeing support they offer staff, there remains scope to ensure that staff feel as though this support is in place. Only half of all staff reported that PAHT take positive action to ensure their health and wellbeing in the Annual Staff Survey
y It is not apparent why the external review of medical rotas to cover establishment and activity was no commissioned in 2022; it would be useful to have an explanation as to why this is the case. Healthwatch Essex endorse the fact a review will be taking place in 2023
y Healthwatch Essex support the wide range of quality improvement programmes taking place within PAHT. It would be helpful to clarify how and why these projects have been successful and to share learnings with partners

y Whilst PAHT recognise the need to improve the long waiting times patients are facing for routine treatment, alongside the backlog of patients waiting longer than 6 weeks for diagnoses, it would be useful for the Trust to itemise the causes for these delays
y Healthwatch Essex endorse the role that PALS play as an advocate for patients and are encouraged that the activities of the service have increased over the past year. It would be useful for PAHT to clarify how they have provided PALS with additional resources to support this growth of activity to ensure the longevity of this service
72 7373
Healthwatch Essex
Feedback from external partners
Dr Kate Mahoney – research manager, Healthwatch Essex (16 May 2023)
Healthwatch Hertfordshire has appreciated the Trust’s desire to hear patient experience in order to improve services, in particular the findings from our cost of living and health inequalities research. The Trust’s Patient Panel has continued to champion the patient voice to ensure quality improvement with the cancer conference being a particular highlight. We look forward to continuing to work closely with the Trust, patient experience team and Patient Panel.
priorities. Progress against all the priorities will be monitored through the Trust’s Quality and Safety Committee.
In regard to the delivery of the national cancer standards, these have continued to be impacted by the number of patients waiting over 62 days for treatment due to Covid-19, however significant progress has been made in reducing the long waits. The Trust achieved the national requirement to reduce the backlog of patients back to pre-Covid levels. A current cancer recovery plan has been implemented across all specialties and the Trust is committed to the delivery of all national cancer standards. Good progress is being made with the faster diagnosis standard and the 2 weeks wait first appointment measures.
Steve Palmer Chair Healthwatch Hertfordshire

May 2023
NHS Hertfordshire and West Essex Integrated Care Board (HWE ICB) response to the Quality Account of The Princess Alexandra Hospital NHS Trust 2022/2023




NHS Hertfordshire and West Essex Integrated Care Board (HWE ICB) welcomes the opportunity to provide this statement on The Princess Alexandra Hospital NHS Trust Quality Account for 2022/23. The ICB would like to thank the Trust for preparing this Quality Account, developing future quality assurance priorities and acknowledging the importance of quality at a time when The Princess Alexandra Hospital NHS Trust continues to deliver services during ongoing challenging periods. We recognise the dedication, commitment and resilience of staff and we would like to thank them for this.
HWE ICB is responsible for the commissioning of health services from The Princess Alexandra Hospital NHS Trust. During the year, HWE ICB have been working closely with The Princess Alexandra Hospital NHS Trust gaining assurance on the quality of care provided that demonstrates it is safe, effective and delivers a positive patient experience. In line with the NHS (Quality Accounts) Regulations 2011 and the Amended Regulations 2017, the information contained within the Trust's Quality Account has been reviewed and checked against data sources, where this is available, and confirm this to be accurate and fairly interpreted to the best of our knowledge.
The Trust has identified seven priorities for 2023/24 that are fundamental elements of their ‘Five P strategy: our patients, our people, our performance, our places and our pounds’. This includes continuing the work to reduce the mortality rate, reducing the number of moderate or severe harm from inpatient falls and hospital acquired pressure ulcers, and also to improve staff well-being. The Trust has provided transparent information in regard to the 2022/23 priorities that were not met and remain ongoing, as well as the next steps going forward for these
The Trust has provided a full and transparent account of the Care Quality Commission (CQC) inspections they have had in year, including the CQC issuing a Section 31 warning notice to the Trust in relation to the Emergency Department. The elements of care that needed review and improvement are detailed in the Quality Account. The Trust continues to focus on their improvement plans and regularly report progress to the Trust's Quality and Safety Committee, the ICB and the CQC.
The Trust has identified many departments and speciality teams within which improvements have been made in the last year, including the teams caring for patients with dementia, case studies in relation to learning from complaints and the continued wide ranging and constructive work of the Patient Panel.
The integrated working with staff and the high esteem with which the Patient Panel are viewed is very clear in the Quality Account.

The Trust reported three never events in year, one investigation has been completed and there has been significant learning and changes in practice to prevent another incident of this type. The other never events remain under investigation and we look forward to receiving updates from these in due course.

Significant learning from patient safety incidents has been demonstrated, specifically in relation to falls improvement work on the respiratory ward, pressure ulcer improvement work related to the care of the elderly wards, and for maternity there has been a new process put in place and a change in guidance as a result of learning from incidents.
The ICB recognises the challenges experienced by the Trust in 2022/23 and we look forward to a continued collaborative working relationship as well as building on existing successes and collectively taking forward needed improvements to deliver high quality services for this year and thereafter.
Toni Coles Place Director, West Essex Hertfordshire and West Essex ICB
74 7575 Healthwatch
Hertfordshire
Glossary of terms
Allied health practitioners - Healthcare professionals working in dietetics, occupational therapy, physiotherapy, operating department assistants, radiography and speech and language therapy. This is distinct from nursing, medicine, pharmacy and healthcare scientists
Ambulatory care - Medical care provided on an outpatient basis, includes diagnosis, observation, consultation, and treatment
Antenatal – This is the care you receive from health professionals during your pregnancy
Anticoagulation - Medicines that help prevent blood clots
Antimicrobial resistance - The ability of a bacteria to resist the effects of medication (antibiotics) that once could successfully treat the infection
Antimicrobial stewardship - A coordinated intervention designed to improve and measure the appropriate use of antimicrobials by promoting the selection of the optimal antimicrobial drug regimen, dose, duration of therapy, and route of administration
Asymptomatic – a condition or person who is showing no symptoms
Audiology - The study of hearing and balance
Bacteraemia – An infection of bacteria in the blood
Cardiac arrest – Sudden loss of blood flow from failure of the heart to pump effectively
Cardiac catheter lab – Procedures of placing catheters (small tubes) into the blood stream to access the heart and blood vessels
Cardiology - The branch of medicine that deals with diseases and abnormalities of the heart
Care Quality Commission (CQC) - CQC is an executive non-departmental public body of the Department of Health United Kingdom. Established in 2009, it is the independent regulator of all health and social care services in England
Chemical pathology – A branch of pathology dealing with biochemical basis for disease
Chemotherapy - The treatment of disease by the use of chemical substances, especially the treatment of cancer by cytotoxic and other drugs
Chronic obstructive pulmonary disease (COPD) - The name for a collection of lung diseases including chronic bronchitis, emphysema and chronic obstructive airways disease
Clinical audits - A process aimed to improve quality of patient care and outcomes through systematic review of care against explicit criteria and the implementation of change
Clinical coding - The process by which patient diagnosis and treatment is translated into standard, recognised codes that reflect the activity that happens to patients
Clostridium difficile (C.difficile)Clostridium difficile, also known as C. difficile, or C. diff, is a type of bacterial infection that can affect the digestive system
Community-onset healthcare associated infection (COHA) – is when an infection is detected when a patient is at home but they have only arrived home within two days of admission to hospital, and the patient was an inpatient in the Trust in the previous four weeks
Colorectal care - Treatments for patients with symptoms of the gastrointestinal tract including colorectal cancer and inflammatory bowel disease
Colposcopy and hysteroscopy services - A procedure used to examine the cervix and inside of the womb (uterus)
CQUIN - Commissioning for Quality and Innovation is a system introduced in 2009 to make a proportion of healthcare providers’ income conditional on demonstrating improvements in quality and innovation in specified areas of care
Datix - Software used in healthcare to collect patient safety incidents and for reporting adverse events
Delirium - Is a state of mental confusion that can happen if you become unwell. It is also known as an acute confusion
Dementia champions - A group of staff who have had specific training in dementia care. Their aim is to make other colleagues more understanding of why a patient may be more challenging and encourages them to tailor therapies accordingly
Dermatology - The branch of medicine concerned with the diagnosis and treatment of skin disorders
Diagnostics - Tools used to help identify disease and illness
Dietetics – A branch of healthcare concerned with the diet and its effects on health, especially with the practical application of a scientific understanding of nutrition
Endocrinology - The branch of physiology and medicine concerned with endocrine glands and hormones
Endoscopy - A procedure that allows a view the inside of a person's body
ENT clinics – An area where diagnosis and treatment are provided to conditions of the ear, nose and throat
Escherichia coli (E.coli) bacteraemia
- Type of bacterial infection and a blood stream infection
Frailty service – Reviews frail older people using a holistic assessment of physical, mental and social needs
Friends and Family Test (FFT) - Test aimed at providing a simple headline metric which, when combined with follow-up questions, is a tool to ensure transparency, celebrate success and galvanise improved patient experience. It asks “How likely are you to recommend our services to friends and family if they needed similar care or treatment?” with answers on a scale of extremely likely to extremely unlikely
Gastroenterology - The branch of medicine which deals with disorders of the stomach and intestines
Genito-urinary - The branch of medicine relating to the genital and urinary organs
Governance - Establishment of policies, and continuous monitoring of their proper implementation, by the members of the governing body of an organisation
Gram negative blood stream infections (GNBSIs) - Type of bacterial infection and a blood stream infection
Gynaecology - The branch of physiology and medicine that deals with the functions and diseases specific to women and girls, especially those affecting the reproductive system
Haematology - The branch of medicine involving the study and treatment of the blood
Healthcare associated infections (HCAI) - Infections that are acquired as a result of healthcare. The burden of healthcare-associated infections has mainly been in hospitals where more serious infections are seen
Health Overview and Scrutiny Committee – Local authority committees that scrutinise health issues and care in their area
Healthwatch – Obtain the views of people about their health needs and
76 7777
experiences of having care and social services
Hospital onset healthcare associated infection (HOHA) – this is an infection that is detected three or more days after admission to hospital therefore considered to be hospital acquired
Hospital Standardised Mortality Ratio (HSMR) - Calculation used to monitor death rates in a Trust
Integrated Care Partnership and System (ICP and ICS) – are alliances of NHS providers that work together to deliver care by agreeing to collaborate rather than compete
Inflammatory bowel disease – The name for a group of conditions that cause the digestive system to become inflamed
Intravenous – Giving fluids or drugs directly into a vein
Klebsiella bacteremia - Type of bacterial infection and a blood stream infection
Laparotomy - A surgical incision into the abdominal cavity, used for diagnosis or in preparation for major surgery
Maternal and Fetal Assessment UnitOutpatient Antenatal Unit offering planned appointments for assessment of the mother and unborn baby in pregnancy
Maxillofacial department – An area where diagnosis and treatment is provided to conditions of the mouth, face and adjacent structures
Medical examiner – senior medical doctors who are contracted for a number of sessions a week to undertake medical examiner duties outside of their usual clinical duties. They are trained in the legal and clinical elements of death certification processes
Medicines optimisation - Is the process of ensuring patients are on the most effective and fewest medications
Methicillin-Resistant Staphylococcus Aureus (MRSA)/Methicillin-Sensitive Staphylococcus Aureus (MSSA) –A specific bacterial infection
Morbidity and mortality (M&M)Meetings established to review deaths as part of professional learning
Myocardial infarction - Commonly known as a heart attack
Myocardial ischaemia - When blood flow to your heart is reduced, preventing the heart muscle from receiving enough oxygen
National Confidential Enquiries (NCEPOD) - National Confidential Enquiry into Patient Outcome and Death
National Reporting and Learning System (NRLS) - A central database of patient safety incident reports
Neonatal (NICU) - New-born children and new-born intensive care unit
Nervecentre – electronic data base where observations are recorded
Neurology - The branch of medicine or biology that deals with the anatomy, functions, and organic disorders of nerves and the nervous system
NHS Digital – the national information and technology partners to the health and social care system
NHSE/I - NHS England and Improvement is responsible for overseeing Trusts and NHS services, as well as independent providers that provide NHS-funded care
NICE - The National Institute for Health and Care Excellence provides guidance, which supports healthcare professionals and others to make sure that the care they provide is of the best possible quality and offers the best value for money
Norovirus - A type of viral infection that can affect the digestive system
Nosocomial – a disease originating in a hospital
Obstetrics - The branch of medicine that deals with the care of women during pregnancy, childbirth, and the recuperative period following delivery
Oesophago-gastric care – Treating patients with problems of the gullet (oesophagus) and stomach
Oncology - The study and treatment of cancer and tumours
Ophthalmology - The study of the structure, functions, and diseases of the eye
Orthopaedic - The branch of medicine that deals with the prevention and correction of injuries or disorders of the skeletal system and associated muscles, joints, and ligaments
Paediatrics - The specialty of medical science concerned with the physical, mental and social health of children from birth to young adulthood
Palliative care - An approach that improves the quality of life of patients and their families facing the problems associated with life-threatening illness, through the prevention and relief of suffering by means of early identification and impeccable assessment and treatment of pain and other problems, physical, psychosocial and spiritual
Pathogen – micro organisms that cause disease
Pathology - The scientific study of the nature of disease and its causes, processes, development and consequences
Patient Advice and Liaison Service (PALS) - Offering confidential advice, support and information on health-related matters. Provides a point of contact for patients, their families and their carers
Patient Panel - A group of volunteers who represent patients, families and carers of The Princess Alexandra
Patient Safety Alerts - Issued by NHS Improvement to rapidly warn the healthcare system of risks. They provide guidance on preventing potential incidents that may lead to harm or death
Perioperative medicine - care of patients from the time of contemplation of surgery through the operative period to full recovery
Personal protective equipment (PPE) - will protect the user against health or safety risks at work, examples are FFP 2/3 face masks medical grade
Polymerase chain reaction (PCR) testing - a method widely used to look for genetic code of the COVID-19 virus, this involves taking a swab of the throat and nose. The test will confirm if a person with symptoms has the virus currently
Point of Care Testing (POC) - such as SAMBA refers to any test that can be undertaken outside of a laboratory
Pressure ulcer – injury to the skin and underlying tissue primarily caused by prolonged pressure on the skin
Pseudomonas – a specific bacterial infection
Rapid Assessment and Treatment (RAT) - A treatment model used in emergency care to provide an early senior assessment and early treatment
Radiology - The branch of medicine that deals with the use of radioactive substances used in the diagnosis and treatment of disease
Referral to Treatment (RTT) – A constitutional standard that trusts are measured against in which a person’s waiting time starts on the day the hospital receives the referral letter from a GP to the time of first appointment or treatment
Respiratory medicine – The branch of medicine that deals with the act of breathing
78 7979
Hospital NHS Trust
Respiratory Syncytial Virus (RSV) – Respiratory syncytial virus is a contagious infection causing infection of the respiratory tract
Rheumatology - The study and treatment of arthritis, autoimmune diseases, pain disorders affecting joints, and osteoporosis

SAFER care bundle – practical tool that uses five elements of best practice
Sepsis and septicaemia - Sepsis is a serious blood stream infection. A serious complication is septicaemia, which is when inflammation occurs throughout the body, which can be life-threatening
Serious Incidents (SIs) - An unexpected or unplanned event that caused harm or had the potential to cause harm to a patient, member of staff, student, visitor or contractor
SMART – mnemonic for objectives that are Specific, Measurable, Achievable, Realistic and Timely
Stakeholders - A stakeholder is anyone with an interest in a business. Stakeholders are individuals, groups or organisations that are affected by the activity of the business. They include owners who are interested in how much profit the business makes
Standard Operating Procedures – A set of step-by-step instructions compiled to help workers carry out complex routine work, aimed to achieve efficiency and uniformity of performance
Standardised Mortality ratio (SMR) and Summary Hospital-level Mortality Indicator (SHMI) - Ratio between the actual number of patients who die following treatment at the trust and the number that would be expected to die, based on average England figures given the characteristics of the patients treated there
Streptococcus – a type of bacteria causing infection
Structured judgement review – allows trained reviewers to identify and describe the quality of care received and in so doing can create a score of that quality
Trauma Audit and Research Network (TARN) – An audit where information is collected and analysed for patients who are moderately or severely injured after an injury. Data is submitted by trusts and a comparison can be undertaken
UK Health Security Agency (UKHSA) –responsible for protecting every member of every community from the impact of infectious diseases
Urology - The study of urinary organs in females and the urinary and sex organs in males
Vascular surgery – Specialists that treat people with diseases of the circulation, which can be conditions affecting arteries, veins and where there are blockages to the flow of blood
Venous thromboembolism (VTE) - A condition where a blood clot forms in a vein, most commonly in a leg where it is known as deep-vein thrombosis (DVT), a blood clot in the lungs is called a pulmonary embolism (PE)
VTE prophylaxis/ thromboprophylaxis
- The giving of a medicine or treatment to prevent a VTE


Appendix 1: Table 5: Statements of assurance from the Board
Prescribed information Form of statement
1. The number of different types of relevant health services provided or subcontracted by the provider during the reporting period, as determined in accordance with the categorisation of services:
(a) Specified under the contracts, agreements or arrangements under which those services are provided or

(b) In the case of an NHS body providing services other than under a contract, agreement or arrangements, adopted by the provider.
During 2022/23, The Princess Alexandra Hospital NHS Trust (PAHT) has provided a range of health services listed in the directory of services, table 1.
Services are provided by the Trust to Integrated Care Systems (ICS) and are mainly commissioned under standard form NHS contracts.
Our income for 22/23 remained largely based on the adapted finance regime introduced in response to the COVID-19 pandemic and this provided predictability and improved cash flow for the Trust.
The Trust has contracts with our main Integrated Care System (Herts and West Essex) and several other key ICSs together with NHS England (NHSE) to deliver NHS acute services in west Essex.
Our current system partners will continue to work collaboratively with the Trust for the whole of 23/24 as we navigate away from the recent Covid income arrangements to a more activity-based payment by results (PbR) contract.
80 8181
During the year, the Trust subcontracted a small number of services to both other NHS and private providers. Services are generally subcontracted where there is a shortterm capacity constraint, requirement for specialist clinical skills and constraints due to elective recovery in response to the COVID-19 backlog. Subcontracted services during 22/23 included dermatology, endoscopy, urology, diagnostics and general surgery for day case procedures.
The Trust is the lead provider for musculoskeletal (MSK) services and the Urgent Treatment Centre (UTC). Our subcontracting partners include Essex Partnership University NHS Trust (EPUT) (MSK contract) and Commissceo (Urgent Treatment Centre).
Prescribed information Form of statement
1.1 The number of relevant health services identified under entry one in relation to which the provider has reviewed all data available to it on the quality of care provided during the reporting period.
1.2 The percentage that the income generated by the relevant health services reviewed by the provider, as identified under entry 1.1, represents of the total income for the provider for the reporting period under all contracts, agreements and arrangements held by the provider for the provision of or subcontracting of, relevant health services.

We have reviewed all the data available on the quality of care provided by the services listed in table 1.
2. The number of national clinical audits (a) and national confidential enquiries (b) which collected data during the reporting period and which covered the relevant health services that the provider provides or subcontracts.
2.1 The number, as a percentage, of national clinical audits and national confidential enquiries, identified under entry two, that the provider participated in during the reporting period.
2.2 A list of the national clinical audits and national confidential enquiries identified under entry two that the provider was eligible to participate in.
2.3 A list of the national clinical audits and national confidential enquiries, identified under entry 2.1, that the provider participated in.
During 2022-23 there were 49 national clinical audits and six national confidential enquiries covering relevant health services that are provided.
During that period, we have participated in 88% (43) national clinical audits and 83% of those national confidential enquiries that were relevant and which PAHT was eligible to participate in.
The national clinical audits and national confidential enquiries that the Trust was eligible to participate in during 2022-23 are detailed in table 3.
The national clinical audits and national confidential enquiries that we have participated in during 202223 are detailed in table 3.
In 2022-23, total income for the Trust was £339.0m. Of this, £316.7m (95%) was received for the delivery of patient care activities (services listed in table 1).
The most significant element of nonpatient income (£10.7m) related to provision of education and training.
2.4 A list of each national clinical audit and national confidential enquiry that the provider participated in, and which data collection was completed during the reporting period, alongside the number of cases submitted to each audit, as a percentage of the number required by the terms of the audit or enquiry.
The national clinical audits and national confidential enquiries that we have participated in, and for which data collection was completed during 2022-23, are listed alongside the number of cases submitted to each audit or enquiry as a percentage of the number of registered cases required by the terms of that audit or enquiry. These are detailed in Table 3.
82 8383
Prescribed information Form of statement
2.5 The number of national clinical audit reports published during the reporting period that were reviewed by the provider during the reporting period.
2.6 A description of the action the provider intends to take to improve the quality of healthcare following the review of reports identified under entry 2.5.
The reports of two national clinical audits were reviewed by the provider in 2022-23.
y Update to information provided to older breast cancer patients
y Update to fitness assessment for older breast cancer patients
y Work taking place to improve data completeness / submission
y Local audit of DNACPR of adult patients with learning disability
3. The number of patients receiving relevant health services provided or subcontracted by the provider during the reporting period that were recruited during that period to participate in research approved by a research ethics committee within the National Research Ethics Service.
The number of patients receiving relevant health services provided or subcontracted by PAHT in 202223 that were recruited into research studies during the period and approved by a research ethics committee was 782.
2.7 The number of local clinical audit (a) reports that were reviewed by the provider during the reporting period.
2.8 A description of the action the provider intends to take to improve the quality of healthcare following the review of reports identified under entry 2.7.
The reports of 14 local clinical audits were reviewed by the Trust in 202223.
y Stopping of routine full blood count on every patient following elective caesarean section
y Increased teaching relating to fever under 5s
y Provision of counselling at time of booking re. potential timing during induction of labour

y Provision of training on obstetric anal sphincter injury
y Provide education on stratification of severity of acute gallstone pancreatitis (AGP) and acute gallstone cholangitis (AGC)
y Booking patients with mild to moderate AGP as early as possible to improve time to cholecystectomy
y Booking patients with moderate to severe AGC early to improve time to ERCP
y Poster to be developed and displayed on wards to raise awareness and improve documentation on input/output
y Provide education to emergency department staff to increase the frequency of bladder scans on geriatric patients with AKI
4. Whether or not a proportion of the provider’s income during the reporting period was conditional on achieving quality improvement and innovation goals under the Commissioning for Quality and Innovation (CQUIN) payment framework agreed between the provider and any person or body they have entered into a contract, agreement or arrangement with for the provision of relevant health services.
As part of the response to COVID-19 and the adoption of an ‘adapted financial regime’, the basis of the trust’s income was mainly derived from block contract arrangements supplemented by ‘top up’ arrangements.
4.1 If a proportion of the provider’s income during the reporting period was not conditional on achieving quality improvement and innovation goals through the CQUIN payment framework, the reason for this.
As part of the Covid-19 income arrangements for 2022/23, CQUIN has been suspended. These are due to be reinstated in 2023/24.
4.2 If a proportion of the provider’s income during the reporting period was conditional on achieving quality improvement and innovation goals through the CQUIN payment framework, where further details of the agreed goals for the reporting period and the following 12-month period can be obtained.
As part of the Covid income arrangements for 2022/23, CQUIN has been suspended. These are due to be reinstated in 2023/24.
84 8585 Prescribed information Form of statement
Prescribed information Form of statement
5. Whether or not the provider is required to register with the CQC under Section 10 of the Health and Social Care Act 2008.
5.1 If the provider is required to register with the CQC: whether at end of the reporting period the provider is:
(i) registered with the CQC, with no conditions attached to registration.
(ii) registered with the CQC with conditions attached to registration.
If the provider’s registration with the CQC is subject to conditions, what those conditions are, and whether the CQC has taken enforcement action against the provider during the reporting period.
PAHT is required to register with the Care Quality Commission.
6. Removed from the legislation by amendments made in 2011.
7. Whether or not the provider has taken part in any special reviews or investigations by the CQC under Section 48 of the Health and Social Care Act 2008 during the reporting period.
7.1 If the provider has participated in a special review or investigation by CQC:
(a) the subject matter of any review or investigation
(b) the conclusions or requirements reported by the CQC following any review or investigation
The Care Quality Commission issued a Section 31 warning notice in 2021, requiring the Trust to submit initially weekly data. During 2022/3 the Trust was required to submit monthly data.
A robust action plan was completed and all actions are being tracked to ensure they are completed.
The CQC undertook an unannounced focused inspection of the urgent and emergency care department in March 2023. They identified an improvement and have removed the section 31 warning notice from May 2023.
(c) the action the provider intends to take to address the conclusions or requirements reported by the CQC and (d) any progress the provider has made in taking the action identified under paragraph (e) prior to the end of the reporting period.
8. Whether or not during the reporting period the provider submitted records to the secondary uses service for inclusion in the hospital episode statistics, which are included in the latest version of those statistics published prior to publication of the relevant document by the provider.
8.1 If the provider submitted records to the secondary uses service for inclusion in the hospital episode statistics which are included in the latest published data:
(a) the percentage of records relating to admitted patient care which include the patient’s:
(i) Valid NHS number
PAHT submitted records during 2022-23 to the secondary user service for inclusion in the hospital episode statistics, which are included in the latest published data.
The percentage of records in the published data which included:
(a) the percentage of records relating to admitted patient care which include the patient’s:
(i) valid NHS number - 99.9%
(ii) General Medical Practice Code – 99.9%
PAHT has not participated in any special reviews or investigations by the CQC during the reporting period.
(ii) General Medical Practice Code
(b) The percentage of records relating to outpatient care which included the patient’s:
(i) Valid NHS number
(ii) General Medical Practice Code
(b) the percentage of records relating to outpatient care which included the patient’s:
(i) valid NHS number - 99.9%
(ii) General Medical Practice Code - 99.9%
Not applicable.
(c) The percentage of records relating to accident and emergency care which included the patient’s.
(c) the percentage of records relating to emergency care which included the patient’s:
(i) valid NHS number - 99.4%
(ii) General Medical Practice Code - 99.8%
86 8787 Prescribed information Form of statement
Prescribed information Form of statement
9. The provider’s Information Governance Assessment Report overall score for the reporting period as per the Data Security Protection Toolkit (DSPT) grading criteria.
10. Whether or not the provider was subject to the payment by results clinical coding audit at any time during the reporting period by the audit commission.
PAHT Information Governance Assessment Report via the Data Security Protection Toolkit has an overall score for 2022-23 as Standard Met. Substantial assurance received through internal audit review with a rating of high confidence.
PAHT was not subject to the payment by results clinical coding audit during 202223 by the audit commission. However, an internal clinical coding information governance audit was undertaken by an NHS Digital qualified clinical coding auditor.
12. (a) The value and banding of the summary hospital-level mortality indicator (‘SHMI’) for the trust for the reporting period; and
f) Complies with the data quality standards within the data security and protection toolkit
a) SHMI banding is 107.1, which is higher than expected for the period up to November 2022.
For November 2022 it is 109.9 which is ‘within expected’
10.1 If the provider was subject to the payment by results clinical coding audit by the audit commission at any time during the reporting period, the error rates, as percentages, for clinical diagnosis coding and clinical treatment coding reported by the Audit Commission in any audit published in relation to the provider for the reporting period prior to publication of the relevant document by the provider.
11. The action taken by the provider to improve data quality.
Not applicable for 2022/23.
13. 14. 15. 16. 17.
(b) The percentage of patient deaths with palliative care coded at either diagnosis or specialty level for the Trust for the reporting period.
b) Palliative care coding was 4.29% at either diagnosis or speciality level
PAHT will be taking the following actions to improve data quality:
a) a full suite of data quality reports produced daily/weekly and circulated to operational teams for resolution of key issues
b) data quality issues are monitored and addressed through the Trust data quality group
c) data quality updates are provided to the Performance and Finance Committee, Information Governance steering group and Elective Care Operational group
d) respond in full to externally reported data quality issues from NHS Digital and our commissioners
The NHS Digital Data Quality Maturity Index score is 93.1% for December 2021; the national average is 79.1%
e) Conducts full user training and refresher training to support the capture and recording of good quality data, operational processes are reviewed and aligned to system functionality
Furthermore, system user training guides are regularly reviewed and updated
Mental health Trusts Ambulance Trusts Ambulance Trusts Ambulance Trusts Mental health Trusts
18. The Trust’s patient reported outcome measures scores (PROMs) for:
(i) groin hernia surgery
(ii) varicose vein surgery
(iii) hip replacement surgery and
(iv) knee replacement surgery during the reporting period.
Not applicable to our Trust.
EQ5D Index
Hip replacement: 91.30%
Knee replacement: 71.43%
EQ-VAS
Hip replacement: 83.33%
Knee replacement: 57.89%
National EQ5D Index
Hip replacement: 94.50%
Knee replacement: 88.87%
EQ-VAS
Hip replacement: 79.10%
Knee replacement: 71.42%
Monitoring of PROMs for groin hernia and varicose vein surgery was paused.
88 8989 Prescribed information Form of statement
Prescribed information Form of statement
19. The percentage of patients aged:
(i) 0 to 14 and


(ii) (ii) 15 or over
Readmitted to a hospital that forms part of the Trust within 28 days of being discharged from a hospital that forms part of the same organisation during the reporting period.
It has been acknowledged that an error was made in the drafting of the regulations and that the split of patients for this indicator should be:
(i) Percentage of 0 to 15 years readmitted was 12.7%
(ii) 16 years and over readmission rate was 12.8%
The regulations refer to 28-day readmissions rather than 30.
Prescribed information Form of statement
23. The percentage of patients who were admitted to hospital and who were risk assessed for venous thromboembolism during the reporting period.
The last data set we have for this is from the period April 2020 to December 2020.
Data for the period 2022-23 was previously suspended due to Covid and has not been restarted at this time.
24. The rate per 100,000 bed days of cases of C.difficile infection reported within the Trust amongst patients aged two or over during the reporting period.
There were 28 hospital onset cases of Clostridium Difficile reported to the national surveillance database for period April 2022 to March 2023.
20. The Trust’s responsiveness to the personal needs of its patients during the reporting period.
21. The percentage of staff employed by, or under contract to, the Trust during the reporting period who would recommend the Trust as a provider of care to their family or friends.
22. Friends and Family Test
– patient. The data made available by the National Health Service Trust or NHS Foundation Trust by NHS Digital for all acute providers of adult NHS funded care, covering services for inpatients and patients discharged from accident and emergency (types 1 and 2).
Please note: there is a not a statutory requirement to include this indicator in the Quality Account reporting, but provider organisations should consider doing so.
The patient advice and liaison service are our first contact and point of care resolution service and in total responded to 4,248 cases this year, which was a 13% increase from the previous year (4,236 in 2021-22).
The staff survey 2022 results found that 42.1% of staff would be happy with the standard of care provided by the organisation if a friend/relative needed treatment.
25. The number and, where available, rate of patient safety incidents reported within the Trust during the reporting period, and the number and percentage of such patient safety incidents that resulted in severe harm or death.
Rate per 100,000 bed days is 21.7 (based on our own Trust data as this information has not been published for 20-21 by UKHSA).
April 2022 to March 2023: The total number of incidents was 13,901 with 8,118 for patients.
Validated harms:
Severe harm incidents: 1 (0.01%) Death incidents: 0 (0.06%)
The patient Friends and Family Test continued throughout 2022/2023.
Our service users receive a link via text message within 24 hours of being discharged or attending their appointment. The Trust has seen an increase in responses due to this new way of collecting data.
Total annual FFT for 2022/2023 –11.29%
26. Statement on seven-day hospital services - as a trust we are working towards the implementation of seven-day services.
As a Trust, our annual operating plan is focused on recovery of services to meet constitutional standards. As such we are reviewing the workforce and service requirements across the seven-day week.
This will identify where service gaps exist, whether there is a service need to operate across seven days and the resources required. This will feed into future business and service plans in line with the PAHT2030 strategy.
90 9191 Prescribed information Form of statement
Prescribed information Form of statement
27.1 The number of its patients who have died during the reporting period, including a quarterly breakdown of the annual figure.
From 1 April 2022 to 31 March 2023, 1,237 of The Princess Alexandra Hospital NHS Trust patients died. This comprised the following number of deaths each quarter:
Quarter 1: 304
Quarter 2: 280
Quarter 3: 332
Quarter 4: 321
27.2 The number of deaths included in item 27.1 which the provider has subjected to a case record review or an investigation to determine what problems (if any) there were in the care provided to the patient, including a quarterly breakdown of the annual figure.
In relation to 1,237 deaths (item 27.1):
y 257 case record reviews,
y 58 incidents raised on datix:
y 36 are closed of which
y 13 Rapid reviews completed
y 22 incidents remain open, of which:
y 5 having rapid review investigations
y 4 serious incident (SI) investigations are ongoing
The number of deaths in each quarter for which a case record review or a serious investigation was carried out was:
Quarter 1:
y 60 case record reviews
y 11 investigations
y 11 concluded no harm confirmed
Quarter 2:
y 58 case record reviews
y 10 investigations:
y 8 closed, no harm confirmed
y 2 investigations continue
Quarter 3:
y 75 case record reviews
y 21 investigations:
y 13 closed, no harm confirmed
y 8 investigations continue
Quarter 4:
y 64 case record reviews,
y 16 investigations:
y 4 concluded, no harm confirmed
y 12 investigations continue
Prescribed information Form of statement
27.3 An estimate of the number of deaths during the reporting period included in item 27.2 for which a case record review or investigation has been carried out which the provider judges as a result of the review or investigation were more likely than not to have been due to problems in the care provided to the patient (including a quarterly breakdown), with an explanation of the methods used to assess this.
Of the 36 completed investigations into patients who had died, none were found to be a result of problems in the care provided to the patient. All were graded as no harm or minor harm.
Cases referred for a structured judgment review (or called case record review) have data captured on an electronic system called SMART.
All of these cases are rated with an avoidability rating of:
Score 1: Definitely avoidable
Score 2: Strong evidence of avoidability
Score 3: Probably avoidable (more then 50:50)
Score 4: Possibly avoidable, (less than 50:50)
Score 5: Slight evidence of avoidability
Score 6: No evidence of avoidability
All cases with an avoidability score of 1 or 2 are referred for:

y A review by the Trust’s learning from deaths panel
y Are logged on Datix as a clinical incident and investigated through this process
y Reviewed by the Trust’s Incident Management Group – level of investigation is decided
y For discussion and learning at the specialty mortality and morbidity meeting
92 9393
27.4 A summary of what the provider has learnt from case record reviews and investigations conducted in relation to the deaths identified in item 27.3.
In year as no cases of validated deaths were due to quality of care given to patients there is no learning to detail in this section.
Prescribed information Form of statement
27.5 A description of the actions which the provider has taken in the reporting period, and proposes to take following the reporting period, in consequence of what the provider has learnt during the reporting period (see item 27.4).

27.6 An assessment of the impact of the actions described in item 27.5, which were taken by the provider during the reporting period.
27.7 The number of case record reviews or investigations finished in this reporting period which related to deaths during the previous reporting period but were not included in item 27.2 in the relevant document for that previous reporting period (2021/22).
27.8 An estimate of the number of deaths included in item 27.7 which the provider judges as a result of the review or investigation were more likely than not to have been due to problems in the care provided to the patient, with an explanation of the methods used to assess this.
27.9 A revised estimate of the number of deaths during this reporting period stated in item 27.3, and for that previous reporting period, taking account of the deaths referred to in item 27.8.
In year as no cases of validated deaths are due to quality of care given to patients there are no actions or learning to detail in this section.
28 In response to the Gosport Independent Panel Report, provide details of ways in which staff can speak up (including how feedback is given to those who speak up) and how we ensure staff who speak up do not suffer detriment. This disclosure should explain the different ways in which staff can speak up if they have concerns over quality of care, patient safety or bullying and harassment.
There are a number of ways in which our people can speak up. This may be to raise concerns about behaviours, patient or staff safety, either as an individual or as a witness, or to give suggestions for improvements.
Nil.
There were 324 incidents that were reviewed in this reporting period for incidents occurring in 2021/22.
There were two incidents that were deemed as more likely than not to have been due to problems in the care provided to the patients during 2021/22.
y None for 2022/23
y Two for 2021/22
y The total is two
We have a Freedom to Speak Up vision and strategy and the vision states: “We are striving to ensure that our people feel enabled to speak up in order to support and improve patient safety and quality, the health and wellbeing of our people, and staff experiences. We are working hard to drive and support a positive culture at the Trust by removing barriers to speaking up and to continuously learn from feedback.”
We have a lead Freedom to Speak Up Guardian, along with four other Freedom to Speak Up Guardians. There is also a Safe Working Guardian in place to support doctors in training.
A number of initiatives have taken to place to raise the profile of speaking up. These include:

y Freedom to Speak Up newsletters
y Presentations for all new staff
y Attending wards/departments
y Posters
y Listening events
94 9595 Prescribed information Form of statement
Over the past year we have appointed and trained 10 Freedom to Speak Up ambassadors. Their role is to support staff to speak up, raise the profile of the service and be accessible to a wider range of staff. The Guardians submit a quarterly report to the National Guardians' Office with numbers of referrals and themes. A more detailed report is presented to the People Committee and the Trust board bi-annually. This shares numbers and themes of concerns raised to them but also the actions taken or required to happen to improve staff and patient experience and safety.
The lead guardian collaborates with a range of key individuals across the Trust to ensure there is triangulation of all feedback from staff and this includes the professional nurse advocate lead, the equality, diversity and inclusion lead, the people team and staff side. Staff can also contact a range of people directly within the organisation who can sign post them for advice and support. These include:
y The people team
y Staff side

y Equality, inclusion and diversity lead
y Line managers
y Tutors
y Organisational development
29. Following the terms and conditions of service for NHS doctors and dentists in training (England) 2016, this requires a consolidated annual report on rota gaps and the plans to reduce rota gaps.
y Staff health and wellbeing
y Mental Health First Aiders
y Professional Nurse/Midwife Advocates
y Freedom to Speak Up ambassadors
Anyone who speaks up is always thanked for doing so. They are assured of confidentiality and encouraged to report immediately if they suffer any detriment from speaking up. This is taken very seriously and will be formally investigated. They are kept informed of progress of any actions taken to improve or resolve issues and asked to feedback on their experience.
Annual surveys and regular Pulse surveys are undertaken to monitor impact of any changes made to improve experience and actions are monitored locally and centrally for themes and improvements.
The Trust did not complete an annual report in 2022/23.
96 9797 Prescribed information Form of statement
Prescribed information Form of statement
The Princess Alexandra Hospital NHS Trust, Hamstel Road, Harlow, Essex, CM20 1QX




01279 44 44 55
NHSHarlow
@NHSHarlow
@PrincessAlexandraNHS
The Princess Alexandra Hospital NHS Trust
98 -